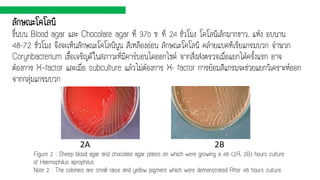
ลักษณะโคโลนี
ขึ้นบน Blood agar และ Chocolate agar ที่ 37o ซ. ที่ 24 ชั่วโมง โคโลนีเล็กมากขาว, แห้ง อบนาน
48-72 ชั่วโมง จึงจะเห็นลักษณะโคโลนีนูน สีเหลืองอ่อน ลักษณะโคโลนี คล้ายแบคทีเรียแกรมบวก จาพวก
Corynbacterium เชื้อเจริญดีในสภาวะที่มีคาร์บอนไดออกไซด์ จากสิ่งส่งตรวจเมื่อแยกได้ครั้งแรก อาจ
ต้องการ X–factor และเมื่อ subculture แล้วไม่ต้องการ X- factor การย้อมสีแกรมจะช่วยแยกวิเคราะห์ออก
จากกลุ่มแกรมบวก
Figure 2 : Sheep blood agar and chocolate agar plates on which were growing a 48 (2A, 2B) hours culture
of Haemophilus aprophilus.
Note 2 : The colonies are small raise and yellow pigment which were demonstrated After 48 hours culture.
2A 2B

Recommended
PPTX
Bacteria gram positive bacilli
PDF
เชื้อแบคทีเรียแกรมบวกBac.Gram+
PDF
PDF
PDF
แบบฝึกทักษะวิทยาศาสตร์ เรื่อง สิ่งรอบตัวเรา ชั้นประถมศึกษาปีที่ 1
PDF
ระบบน้ำเหลืองและระบบภูมิคุ้มกัน (1- 2560)
PPTX
แบคทีเรียแกรมบวกรูปร่างกลม(The Gram Positive Cocci)
PDF
PDF
PDF
ชีววิทยาของจุลินทรีย์และความรู้เบื้องต้นทางเภสัชจุลชีววิทยา by pitsanu duan...
PPT
PPTX
Bacterial Gram- positive Cocci
PDF
PDF
ฮอร์โมนจากต่อมไร้ท่อและอวัยวะสำคัญ
PDF
PDF
PDF
การพยาบาลผู้ป่วยที่มีปัญหา ของระบบทางเดินหายใจ
PPT
PPT
การวัดและประเมินผลการเรียนรู้
PPTX
โครงงานวิทยาศาสตร์หัวหอมเเดง
PDF
PDF
วิทยาศาตร์พื้นฐาน ม1เทอม1
PDF
ระบบภูมิคุ้มกัน (Immune system) by pitsanu duangkartok
PPT
TAEM10: Endocrine Emergency - Nurse
PDF
PDF
PDF
กระบวนการบำบัดรักษาผู้ป่วยยาและสารเสพติดแนวใหม่
PDF
PPTX
PPTX
More Related Content
PPTX
Bacteria gram positive bacilli
PDF
เชื้อแบคทีเรียแกรมบวกBac.Gram+
PDF
PDF
PDF
แบบฝึกทักษะวิทยาศาสตร์ เรื่อง สิ่งรอบตัวเรา ชั้นประถมศึกษาปีที่ 1
PDF
ระบบน้ำเหลืองและระบบภูมิคุ้มกัน (1- 2560)
PPTX
แบคทีเรียแกรมบวกรูปร่างกลม(The Gram Positive Cocci)
PDF
What's hot
PDF
PDF
ชีววิทยาของจุลินทรีย์และความรู้เบื้องต้นทางเภสัชจุลชีววิทยา by pitsanu duan...
PPT
PPTX
Bacterial Gram- positive Cocci
PDF
PDF
ฮอร์โมนจากต่อมไร้ท่อและอวัยวะสำคัญ
PDF
PDF
PDF
การพยาบาลผู้ป่วยที่มีปัญหา ของระบบทางเดินหายใจ
PPT
PPT
การวัดและประเมินผลการเรียนรู้
PPTX
โครงงานวิทยาศาสตร์หัวหอมเเดง
PDF
PDF
วิทยาศาตร์พื้นฐาน ม1เทอม1
PDF
ระบบภูมิคุ้มกัน (Immune system) by pitsanu duangkartok
PPT
TAEM10: Endocrine Emergency - Nurse
PDF
PDF
PDF
กระบวนการบำบัดรักษาผู้ป่วยยาและสารเสพติดแนวใหม่
PDF
Similar to Presentation2
PPTX
PPTX
PDF
PPTX
Pathogenic Gram-Negative Bacilli�(Oxidase -)
PDF
PDF
Introduction to bacteriology,morphology and classification of bacteria
PPTX
PPTX
Gram negative bacteria bacilli oxidase negative
PPTX
Bacteria Gram-Negative Bacilli Oxidase -
DOC
PPT
2การจัดลำดับความสำคัญโรคติดต่อนำโดยแมลง
PPTX
PDF
ความหลากหลายของปรสิต ก่อให้เกิดโรคในคน by Pitsanu Duangkartok
PPT
PPTX
PPTX
Gram negative-oxidase-positive
PDF
PPTX
PPTX
Gram negative bacilli oxidase -
PDF
Presentation2 1. 2. Pasteurellaceae
Pasteurellaceae เป็นกลุ่มของ Proteobacteria และเป็นเพียงสมาชิกลาดับ Pasteurellales เท่านั้น
แบคทีรีย Gram – negative , rod-shaped หรือ cocci มีลักษณะ แตกต่างจาก แบคทีเรีย
Enterobacteriaceae เมื่อมี oxidase และแบคทีเรียที่คล้ายกันมากที่สุดเนื่องจากไม่มี flagella บางชนิด
เป็น pleomorphic และเปลี่ยนรูปร่าง มักจะสามารถสังเกตการก่อตัวของเส้นใย
ในครอบครัวนี้มีบางสายพันธุ์ที่ทาให้เกิดโรคเช่นมนุษย์ Haemophilus influenzae
3. Pasteurella
Pasteurella เป็นเชื้อแบคทีเรียที่ไม่ใช่ออกซิเจนในรูป Gram – negative
Pasteurella species ไม่ใช่ motile และ pleomorphic และมักแสดงการย้อมสีสองขั้ว
("safety pin" appearance)
ส่วนใหญ่เป็นสายพันธุ์ catalase และ oxidease - positive
หลายสายพันธุ์ Pasteurella เป็นเชื้อโรคจากสัตว์ และมนุษย์สามารถติดเชื้อจากสัตว์กัดได้
ในสัตว์แทะและนกสายพันธุ์ Pasteurella สามารถทาให้เกิดโรคปอดบวมคุกคามชีวิตได้
Pasteurella haemolytica เป็นสายพันธุ์ที่ติดเชื้อส่วนใหญ่เป็นโคและม้า P.multocida เป็นสาเหตุสาคัญ
ที่สุดในการติดเชื้อ Pasteurella ของมนุษย์
4. โรคแบคทีเรีย Pasteurella multocida
Pasteurella multocida มีขนาดเล็ก gram-negative, nonmotile, non-spore-forming coccobacillus
ที่มีคุณสมบัติการย้อมสีแบบ bipolar แบคทีเรียมักจะปรากฏเป็นแบคทีเรียเดี่ยวบนคราบ Gram
สามารถดูคู่และโซ่สั้นได้เช่นกัน multocida มักมีอยู่ใน commensal ในระบบทางเดินหายใจส่วนบนของปศุ
สัตว์สัตว์ปีกและสัตว์เลี้ยงชนิดต่าง ๆ โดยเฉพาะอย่างยิ่งแมวและสุนัข ในความเป็นจริงพันธุ์ Pasteurella เป็น
แบคทีเรีย commensal ที่แพร่หลายมากที่สุดในสัตว์เลี้ยงภายในประเทศและสัตว์ป่าทั่วโลก การติด
เชื้อ multocida ในมนุษย์มักเกี่ยวข้องกับสัตว์กัดรอยขีดข่วนหรือเลีย
5. 6. Haemophilus เป็นเชื้อ Gram-negative pleomorphic แบคทีเรีย coccobacilli ที่เป็นของตระกูล
Pasteurellaceae ในขณะที่เชื้อแบคทีเรีย Haemophilus มักเป็น coccobacilli ขนาดเล็ก จะจัดประเภท
เป็นแบคทีเรีย pleomorphic เนื่องจากรูปทรงที่หลากหลาย สิ่งมีชีวิตเหล่านี้อาศัยอยู่ในเยื่อเมือกของระบบ
ทางเดินหายใจส่วนบนปากช่องคลอดและลาไส้ เชื้อโรคที่สาคัญเช่น H. influensae ซึ่งเป็นสาเหตุของเชื้อ
แบคทีเรียและเยื่อหุ้มสมองอักเสบในเด็ก และ H.drucreyi ซึ่งเป็นสาเหตุของ chancorid สมาชิกทั้งหมดมี
ทั้ง แอโรบิค หรือ แบบไม่ใช้ออกซิเจน สกุลนี้ถูกพบว่าเป็นส่วนหนึ่งของ microbiome น้าลาย
Haemophilus
7. Haemophilus influenzae
- เป็นโรคติดเชื้อสาคัญในเด็กอายุน้อยกว่า 2 ปี
- อุบัติการณ์โรคไม่มากนัก(น้อย)แต่ความรุนแรงมีสูง
- โรคที่เกิดจากเชื้อ HIP ได้แก่ โรคเยื่อหุ้มสมองอักเสบ , ฝาปิดกล่องเสียงอักเสบ, โรคติดเชื้อในกระแสเลือด
โรคปอดอักเสบ, โรคข้ออักเสบ, โรคหูชั้นกลางอักเสบ
-โรคสาคัญที่เชื้อนี้เป็นสาเหตุหลักคือ โรคเยื่อหุ้มสมองอักเสบ , ฝาปิดกล่องเสียงอักเสบ
การติดต่อ เชื้ออยู่ในระบบทางเดินหายใจ แพร่กระจายทางละอองฝอยในอากาศ หรือสัมผัสกับสิ่งคัดหลั่ง
โดยตรง เชื้อ เป็นแบคทีเรียแท่งสั้น gram negative coccobacilli
แบ่งได้ 2 ชนิด
1.มีแคบซูลหุ้ม มี 6 serotype อาศัยความแตกต่างของแคบซูล ที่สาคัญคือ serotype B เนื่องจากมักก่อโรค
รุนแรง
2.ไม่มีแคปซูลหุ้ม มักทาให้ติดเชื้อที่เยื่อบุ เช่น sinusitis, otitis media, bronchitis, pneumonia
8. ระบาดวิทยา
พบบ่อยในเด็ก 6-18 เดือน โดยเฉพาะในโรคที่รุนแรงคือเยื่อหุ้มสมองอักเสบ ในไทยพบน้อยกว่าทางตะวันตก
ปัจจัยเสี่ยงสาคัญ
1.อายุ
2.ภูมิคุ้มกันบกพร่อง: aspleenic syndrome. HIV, hypogammaglobulinemia, thalassemia
3.ผู้ป่วยโรคเรื้อรัง: COPD, smoking, pregnancy, cancer, old age
4.ชุมชนแออัด สถานเลี้ยงเด็ก
พยาธิกาเนิด
เชื้อจับ nonciliated columnar epithelium ของ nasopharynx เข้ากระแสเลือด แล้วไปแสดงอาการที่
อวัยวะต่างๆ ที่พบบ่อย เยื่อหุ้มสมอง ฝาปิดกล่องเสียง ปอดอักเสบ
9. อาการทางคลินิก
1.เป็นสาเหตุสาเหตุหลักของ epiglossitis, pericarditis, meningitis
โรคเยื่อหุ้มสมองอักเสบ ไข้ ความรู้สึกตัวเปลี่ยนแปลง ซึม สับสน คอแข็ง
ในเด็กเกิดจากเชื้อนี้ 35-44% ในไทยมีจานวนไม่มาก 3.8 ต่อ100,000 รายที่อายุน้อยกว่า 5 ปี ต่อปี แต่ทาง USA
พบ 41:100,000รายต่อปี แต่หลังมีวัคซีนลดลงจนเกือบไม่พบ
ปัญหาคือ โรคนี้แม้รักษาถูกต้องแล้วแต่ ยังมีอัตราการเสียชีวิตสูง ประมาณ 20-60% และมีภาวะแทรกซ้อนได้มาก เช่น
พัฒนาการช้า, cerebral palsy, การได้ยินลดลง, ชัก
ในเด็กเล็กพบ bacterial meningitis น้อย เชื้อที่พบได้เช่น HIB,N.meningitidis, Strep.pneumo. เป็นต้น ในกลุ่ม
แบคทีเรียพบ HIB มากสุดแต่ก็ยังน้อย
ฝาปิดกล่องเสียงอักเสบ พบเชื้อนี้เป็นสาเหตุถึง 75-90% ไข้สูง กลืนลาบาก ทางเดินหายใจอุดกั้น รักษาไม่ทันอาจ
เสียชีวิตได้
2.ชนิดไม่มีแคปซูล เป็นสาเหตุของ หูชั้นกลางอักเสบ ไซนัสอักเสบ ซึ่ง HIP ก็ทาให้เกิดได้
3.ส่วนปอดอักเสบแยกยากจากเชื้อแบคทีเรียตัวอื่น
10. การวินิจฉัย
1.gram stain จากสิ่งส่งตรวจ : CSF, pleural fluid, pus พบ gram negativepleomorphic
coccobacilli
2.culture จาก: blood. pleural fluid, pus
3.ตรวจ Antigen: latex particle agglutination test, countercurrent
immunoelectrophoresis
และการส่งตรวจ PCR
การรักษา
ยากลุ่ม beta-lactam : amoxicillin, 2nd -3rd gen. cephalosporin
ยาอื่น : fluoroquinolone,macrolides, tetracycline, aminoglucosides
11. Other Species of Haemophilus
Haemophilus Ducreyi
Chancroid แผลริมอ่อนเป็นโรคที่ติดต่อทางเพศสัมพันธ์ เกิดจากเชื้อแบคทีเรียที่ชื่อว่า Haemophilus Ducreyi
โรคนี้ติดต่อได้ง่าย แต่ก็สามารถรักษาให้หายขาด โรคนี้จะทาให้เกิดแผลที่อวัยวะเพศ และต่อมน้าเหลืองที่ขาหนีบโต
บางครั้งมีหนองไหลออกมาที่เรียกว่าฝีมะม่วง หากไม่รักษาจะเป็นสาเหตให้เกิดการติดเชื้อ HIV ได้ง่าย
การติดต่อแผลริมอ่อน Chancroid
- ติดต่อทางเพศสัมพันธ์ มีการสัมผัสแผลระหว่างที่มีเพศสัมพันธ์
- ติดต่อโดยการปนเปื้อนหนองไปติดผิวหนังส่วนอื่น
12. 13. ยาที่ใช้รักษาได้แก่
•Azithromycin 1 gram ครั้งเดียว
•Ceftriaxone 250 mg ฉีดเข้ากล้ามครั้งเดียว
•Ciprofloxacin 500 mg วันละ 2 ครั้งเป็นเวลา 3 วัน ไม่ควรให้ในคนท้อง
•Erythromycin 500 mg วันละ 4 ครั้งเป็นเวลา 7 วัน
แผลมากจะดีขึ้นใน 3-7 วัน ระยะเวลาในการรักษาขึ้นกับขนาดของแผล แผลที่มีขนาดใหญ่อาจจะต้องใช้เวลาในการรักษา 2
สัปดาห์
การป้องกันแผลริมอ่อน
•อย่าสาส่อนทางเพศ
•ใช้ถุงยางอนามัยที่ทาจากยางธรรมชาติ(ป้องกันได้เฉพาะอวัยวะเพศเท่านั้น ผิวหนังส่วนอื่นไม่สามารถป้องกัน)
•หากมีแผลให้งดการมีเพศสัมพันธ์
โรคแทรกซ้อนแผลริมอ่อน
•เนื่องจากเป็นแผลทาให้เกิดการติดเชื้อ HIV ง่ายขึ้น
•ต่อมน้าเหลืองที่ขาหนีบอาจจะอักเสบจนแตกเป็นหนองไหลออกมา หากไม่รักษาใน 5-8วันหลังจากเกิดแผล
•แผลอาจจะเกิดการติดเชื้อแบคทีเรีย
•หากเป็นแผลที่หนังอวัยวะเพศชายอาจจะเกิดพังผืด
14. Haemophilus aphrophilus
รูปร่างเซลล์
Haemophilus aprophilus เป็นสมาชิกของแบคทีเรีย HACEK (Haemophilus aphrophilus,
Actinobacillus actinomycetemcomitans, Cardiobacterium hominis, Eikenella
corrodens, Kingella spp.) ที่มีความสัมพันธ์กับการเกิดโรค subacute bacterial
endocarditis
รูปร่างเซลล์ แกรมลบแท่งบาง สั้น oval, อาจพบเป็น filament, pleomorphic
พบเป็นปกติในระบบทางเดินหายใจส่วนบน
15. ลักษณะโคโลนี
ขึ้นบน Blood agar และ Chocolate agar ที่ 37o ซ. ที่ 24 ชั่วโมง โคโลนีเล็กมากขาว, แห้ง อบนาน
48-72 ชั่วโมง จึงจะเห็นลักษณะโคโลนีนูน สีเหลืองอ่อน ลักษณะโคโลนี คล้ายแบคทีเรียแกรมบวก จาพวก
Corynbacterium เชื้อเจริญดีในสภาวะที่มีคาร์บอนไดออกไซด์ จากสิ่งส่งตรวจเมื่อแยกได้ครั้งแรก อาจ
ต้องการ X–factor และเมื่อ subculture แล้วไม่ต้องการ X- factor การย้อมสีแกรมจะช่วยแยกวิเคราะห์ออก
จากกลุ่มแกรมบวก
Figure 2 : Sheep blood agar and chocolate agar plates on which were growing a 48 (2A, 2B) hours culture
of Haemophilus aprophilus.
Note 2 : The colonies are small raise and yellow pigment which were demonstrated After 48 hours culture.
2A 2B
16. การทาให้เกิดโรค
เป็น opportunistic pathogen เป็นสาเหตุของ
- Endocarditis (uncommon)
- Subacute bacterial endocarditis
- Sinusitis, otitis media
- Pneumonia, empyema
- Septicemia, endocarditis
- Septicarthritis, osteomyelitis
- Soft tissue abscess, brain abscess
- Wound infections
การวินิจฉัยทางห้องปฏิบัติการ
1. สิ่งส่งตรวจ
Pleural fluid, abdominal drainage, blood, CSF,
abscess (brain และอื่นๆ) sputum, bronchus,
throat, wound, sinus, eyes
2. การตรวจจุลชีพจากสิ่งส่งตรวจ (Figure 3)
สีแกรมปกติใช้ safranin O เป็นสีย้อมทับ H.
aphrophilus จะติดสีจาง ใช้ย้อมทับด้วย carbol
fuchsin* จะเห็นเซลล์ติดสีชัดเจน รูปร่างเซลล์
coccobacilli แยกไม่ได้จากแกรมลบอื่นๆ
17. Bartonella
Bartonella เป็นแคทีเรียแกรมลบ มันเป็นสกุลเดียวในครอบครัว Bartonellaceae พยาธิภายใน
เซลล์ Bartonella สามารถติดเชื้อได้คนที่มีสุขภาพดี แต่ถือว่าเป็นเชื้อโรคฉวยโอกาส ความสาคัญเป็น
พิเศษ ชนิด Bartonella จะถูกส่งโดย เวกเตอร์ เช่น เห็บ หมัด แมลงวันทราย และ ยุง อย่างน้อยแปดชนิด
หรือ จาพวก Bartonella เป็นที่รู้จักแพร่ระบาดของมนุษย์ Bartonella henselae เป็นสิ่งมีชีวิตที่ก่อให้
โรคเกา
18. Bartonella henselae ซึ่งเคยเป็น Rochalima เป็น proteobacterium ซึ่งเป็นสาเหตุของ
โรค cat-scratch ( bartonellosis )
Bartonella henselae
โรคแมวข่วน (Cat scratch disease) ย่อว่าโรคซีเอสดี (CSD) เป็นโรคเกิดจากร่างกายติดเชื้อ
แบคทีเรีย (ชนิดแกรมลบ) ในสกุล/Genus ที่ชื่อ Bartonella โดยชนิด/Species ที่มักก่อโรคในคนคือ
Bartonella henselae (B. henselae) ซึ่งไข้แมวข่วนจัดเป็นโรคหนึ่งที่รวมอยู่ในกลุ่มโรคที่เรียกว่า
“Bartonellosis โรคต่างๆที่เกิดจากแบคทีเรียสกุล Bartonella” โดยเชื้อจะอาศัยอยู่ในต่อมน้าลายของแมวแต่ไม่
ก่ออาการในแมว ซึ่งเชื้อจะมีอยู่ในน้าลายติดอยู่ที่ขนและติดที่เล็บของแมว
19. ลักษณะโรค : เป็นโรคติดเชื้อแบคทีเรียชนิดกึ่งเฉียบพลันสามารถหายได้เอง โรคแมวข่วน อาจเกิดความสับสนกับ
โรคอื่นๆ ที่เกิดอาการต่อมน้าเหลืองโตได้ เช่น โรคทูลารีเมีย,บรูเซลโลสิส, ทูเบอร์คูโลสิส, กาฬโรค, โรคพลาส
เจอเรลโลซิส (Pasteurellosis) และโรคมะเร็งต่อมน้าเหลือง
มีสาเหตุจากการติดเชื้อ Bartonella henselae (ดังรูปที่ 29) มีลักษณะเป็น facultative
intracellularparasites ติดสีแกรมลบ รูปร่างแบบท่อนเคลื่อนที่ได้ด้วย fl agellae เป็นเชื้อฉวยโอกาส
(opportunisticpathogens) สามารถติดเชื้อในคนได้ โดยมีพาหะเป็นพวกแมลง เช่น หมัด, ริ้นฝอยทราย
(sand fl ies) และยุง
รูปที่ 29 ลักษณะโคโลนีที่ลื่นและขรุขระของ B. henselae ที่เจริญบนอาหารเลี้ยงเชื้อ chocolate agar
(กาลังขยาย 40 เท่า) (Smooth and verrucous colonytypes growing concurrently in a
chocolateagar culture of B. Henselae)
20. ระบาดวิทยา
พบเกิดขึ้นทั่วสหรัฐอเมริกา อุบัติการณ์จะมากขึ้นในพื้นที่ที่มีอุณหภูมิสูงขึ้นและความชื้น (เช่น , ฮาวาย, แปซิฟิก
ตะวันตกเฉียงเหนือ ทิศตะวันออกเฉียงใต้ของรัฐชายฝั่งแคลิฟอร์เนีย),ในขณะที่อลาสกา, เทือกเขาร็อกกี้และมิดเวสต์ของรัฐมี
ความชุกที่ต่ากว่าค่ามัธยฐาน เพียง 1 ยีนของ B.henselae ที่เคยมีรายงานในอเมริกาเหนือ ประมาณ70-90% ของโรคแมว
ข่วน เกิดขึ้นในเดือนฤดูใบไม้ร่วงและฤดูหนาวในช่วงต้นฤดูกาลนี้เป็นสันนิษฐานว่าจะเกิดขึ้นในฤดูร้อนที่เกิดมาพร้อมกับลูกแมว
หมัดรบกวนเพิ่มขึ้น
อาการของโรค : มีอาการวิงเวียน ต่อมน้าเหลืองอักเสบโตเป็นก้อน (granulomatous lymphadenitis) และมีไข้ได้
หลายแบบ เกิดแผลเป็นผื่นสีแดง เกี่ยวเนื่องจากต่อมน้าเหลืองภายใน 2 สัปดาห์ และพัฒนากลายเป็นหนองผู้ป่วยร้อยละ 50
- 90 เกิดผดขึ้นบริเวณที่ถูกแมวข่วนกลุ่มอาการ Parinaud Oculoglandular Syndrome(granulomatous
conjunctivitis with pretragala denopathy) เกิดขึ้นหลังจากการติดเชื้อตาแดงโดยตรงหรือโดยอ้อม และอาจเกิดอาการ
แทรกซ้อนทางระบบประสาท เช่น สมองอักเสบ และ ระบบประสาทตาอักเสบ(optic neuritis) ได้ อาการไข้สูงเรื้อรังอาจเกิด
ร่วมกับรอยโรคของกระดูกที่มีการสลายหรือแทนที่เนื้อกระดูกด้วยสิ่งอื่นๆ และ/หรือการเกิดก้อนที่ตับ และม้าม
21. การวินิจฉัยโรค : การวินิจฉัยโรคจะใช้อาการทางคลินิกที่สอดคล้องกับหลักฐานการตรวจแอนติบอดีทาง
ภูมิคุ้มกันต่อเชื้อ Bartonella henselae ที่ตรวจพบไตเตอร์ 1/64หรือมากกว่า จากการตรวจ IFA ที่ให้ผล
บวก
การรักษา : ผู้ป่วยมีภูมิคุ้มกันโรคปกติ และไม่มีโรคแทรกซ้อนจะหายได้เอง โดยไม่ต้องใช้ยารักษา แต่สาหรับ
ผู้ป่วยที่มีภูมิต้านทานต่า ต้องรักษาเป็นเวลา 1-3 เดือน ด้วยการให้ยาปฏิชีวนะ เช่น อีริโทรมัยซิน
(Erythromycin), ไรแฟมปิซิน (Rifampicin), ซิโพรโปรฟล็อกซาซิน (Ciprofl oxacin) หรือเจนตามิซิน
(Gentamicin) ในรายที่ต่อมน้าเหลืองอักเสบ เป็นหนอง การใช้เข็มเจาะให้หนองออกมาก็สามารถลดอาการปวด
ลงได้ แต่แนะนาให้หลีกเลี่ยงการตัดชิ้นเนื้อจากต่อมน้าเหลืองไปตรวจ
22. Bartonella quintana
B. quintana เป็น แบคทีเรียชนิดแบคทีเรียชนิด ก้าน (แบคทีเรีย แอนโบบิก แบคทีเรียแกรมลบ) การติดเชื้อที่
เกิดจากจุลินทรีย์นี้เป็นไข้ที่ได้รับการพิสูจน์เป็นครั้งแรกในหมู่ทหารในช่วงสงครามโลกครั้งที่หนึ่ง แต่ปัจจุบัน
ได้รับการเห็นในยุโรปเอเชียและแอฟริกาเหนือ เวกเตอร์หลักของมันเป็นที่รู้จักกันในชื่อ Pediculus humanus
corporis หรือเรียกอีกชื่อว่า body louse ของ
23. 24. อาการทางคลินิก
B. quintana และ Mycobacterium avium complex ร่วมกับผู้ป่วยโรคเอดส์
อาการทางคลินิกของการติดเชื้อ B. quintana มีความแตกต่างกันอย่างมาก ระยะฟักตัว เป็นที่รู้กันว่าเป็นเวลา
5-20 วัน ซึ่งต่างจากความคิดเดิมที่อยู่ระหว่าง 3-38 วัน การติดเชื้อสามารถเริ่มต้นได้เมื่อมีอาการรุนแรงของ
ช่วงไข้อาการกาเริบของไข้หรือเป็นโรคไทฟอยด์ถาวร; อาการ ตาแดง,ปวดศีรษะและกล้ามเนื้อ,
มี splenomegaly น้อยกว่าปกติ ผู้ป่วยส่วนใหญ่มีอาการปวดบริเวณขาล่าง (shins) ปวดกล้ามเนื้อบริเวณ
ขาและข้างหลังและการ แข็งตัว ของ เส้นประสาท ไม่ค่อยมีการติดเชื้อ B. quintana ร้ายแรงเว้นแต่
endocarditis พัฒนาและไม่ผ่านการบาบัด การลดน้าหนักและ thrombocytopenia บางครั้งก็เห็น การกู้คืน
อาจใช้เวลาถึงหนึ่งเดือน
25. การวินิจฉัยและการรักษา
การวินิจฉัยว่ามีการติดเชื้อ B. quintana จาเป็นต้องใช้เทคนิคการเพาะเลี้ยง serological หรือเทคนิคการ
ขยายกรดนิวคลีอิก เพื่อแยกความแตกต่างระหว่างชนิดต่างๆการตรวจวัด immunofluorescence ที่ใช้
antisera ของเมาส์ถูกนามาใช้เช่นเดียวกับ การผสมผสาน DNA และการจากัดความยาวของความยาวส่วนที่
จากัด หรือลาดับเบสของ cytrate synthase การรักษามักประกอบด้วย 4-6 สัปดาห์ของหลักสูตร
doxycycline , erythromycin หรือ azithromycin
26. brucella
Brucella เป็น เชื้อแบคทีเรียชนิดแกรมลบ มีขนาดเล็ก (0.5 ถึง 0.7 โดย 0.6 ถึง 1.5 μm) ไม่
ห่อหุ้ม ไม่เคลื่อนที่ coccobacilli intracellular ภายใน Brucella เป็นสาเหตุของ brucellosis ซึ่งเป็น
zoonosis ที่ ส่งผ่านการกินอาหารที่ปนเปื้อน (เช่นผลิตภัณฑ์นมที่ ไม่ผ่านการพาสเจอร์ไรส์ ) การสัมผัส
โดยตรงกับสัตว์ที่ติดเชื้อหรือการสูดดมละอองลอย การส่งผ่านจากมนุษย์สู่มนุษย์เช่นผ่านการมีเพศสัมพันธ์หรือ
จากมารดาถึงเด็กเป็นเรื่องยากมาก แต่เป็นไปได้ การติดเชื้อต่าสุดคือระหว่าง 10 และ 100 สิ่งมีชีวิต ชนิดที่
แตกต่างกันของ Brucella มีลักษณะคล้ายคลึงกันทางพันธุกรรมแม้ว่าแต่ละชนิดจะมีความจาเพาะเฉพาะของ
โฮสต์ที่แตกต่างกันเล็กน้อย ดังนั้นอนุกรมวิธาน NCBI รวมถึงสายพันธุ์ Brucella ส่วนใหญ่ภายใต้ B.
melitensis
27. Brucellosis
brucellosis ของมนุษย์มักไม่ถูกส่งจากมนุษย์สู่คน คนติดเชื้อจากการสัมผัสกับของเหลวจากสัตว์ที่ติด
เชื้อ (แกะโคหรือสุกร) หรือผลิตภัณฑ์อาหารที่ได้จากสัตว์ เช่น นมและชีส ที่ไม่ผ่านการฆ่าเชื้อ Brucellosis
เป็นโรคที่เกิดจากการประกอบอาชีพเนื่องจากมีอุบัติการณ์สูงขึ้นในคนที่ทางานกับสัตว์ (กรณีโรงฆ่าสัตว์) คน
อาจติดเชื้อด้วยการสูดดมฝุ่นละอองหรือละอองฝอยที่ปนเปื้อนและด้วยเหตุนี้ CDC จึงติดฉลากว่า Brucella
species เป็นอย่างมากที่สามารถสร้างอาวุธได้ มนุษย์และสัตว์ brucellosis ร่วมกันคงอยู่ของแบคทีเรียใน
เนื้อเยื่อของระบบ phagocyte mononuclear ได้แก่ ม้าม ตับ ต่อมน้าเหลือง และ ไขกระดูก Brucella ยัง
สามารถกาหนดเป้าหมายระบบสืบพันธุ์เพศชาย
28. Brucellosis อาจมีผลต่อระบบอวัยวะหรือระบบอวัยวะใด ๆ และ 90% ของผู้ป่วยมีไข้แบบวัฏจักร (ยุ้ยอ่อน) แม้ว่าตัว
แปรอาการต่างๆอาจรวมถึงอาการทางคลินิกเหล่านี้ เช่น ปวดศีรษะ อ่อนเพลีย ปวดข้อปวด หดหู่ การสูญเสียน้าหนัก
ความเมื่อยล้า และความผิดปกติของตับ เหงื่อเหม็น 20 และ 60% ของผู้ป่วยมีภาวะแทรกซ้อนเกี่ยวกับข้อเข่าเสื่อม - โรค
ข้ออักเสบ, spondylitis หรือ osteomyelitis อาจเกิดภาวะตับวายขึ้นเนื่องจากภาวะแทรกซ้อนทางเดินอาหาร
ถึง 20% ของกรณีที่สามารถมีส่วนร่วมอวัยวะสืบพันธุ์; orchitis และ epididymitis เป็นส่วนใหญ่ อาการทางระบบ
ประสาท ได้แก่ ภาวะซึมเศร้าและความเมื่อยล้าทางจิต การมีส่วนร่วมของหลอดเลือดสามารถรวมถึงการเกิด
endocarditis ทาให้เสียชีวิตได้
brucellosis เรื้อรังเป็นเรื่องยากที่จะกาหนด; ความยาวประเภทและการตอบสนองต่อการรักษาเป็นตัวแปร อาจเกิดการ
ติดเชื้อเฉพาะที่ ไม่ควรยอมรับการบริจาคโลหิตของผู้ติดเชื้อ
ทารกแรกเกิดที่ติดเชื้ออาจมีน้าหนักแรกเกิดน้อยความล้มเหลวในการเจริญพันธุ์โรคดีซ่านตับ hepatomegaly ความ
เหนื่อยล้าความยากลาบากในการหายใจและสัญญาณแบคทีเรียทั่วไป (ไข้อาเจียน) บางกรณีไม่มีอาการ
29. Bordetella
Bordetella เป็นเชื้อที่มี ขนาดเล็ก (0.2 - 0.7 μm), Gram-negative coccobacilli ของ Proteobacteria
ในหลอดเลือด ชนิดของ Bordetella ยกเว้น B. petrii เป็น aerobes ที่จาเป็น เช่นเดียวกับความพิถีพิถันหรือ
ยากที่จะเพาะเลี้ยง ทุกสายพันธุ์สามารถติดเชื้อได้ สามชนิดแรกที่ได้รับการอธิบาย
( B. pertussis , B. parapertussis ,B. bronchiseptica) บางครั้งเรียกว่า สายพันธุ์คลาสสิก หนึ่งใน
เหล่านี้ (B. bronchiseptica) ยังเคลื่อนที่ได้
30. Bordetella pertussis
Bordetella pertussis โรคไอกรน เป็นโรคติดเชื้อของระบบทางเดินหายใจ ทาให้มีการอักเสบของเยื่อ
บุทางเดินหายใจ และเกิดอาการไอ ที่มีลักษณะพิเศษคือ ไอซ้อนๆ ติดๆ กัน 5-10 ครั้ง หรือมากกว่านั้นจนเด็ก
หายใจไม่ทัน จึงหยุดไอ และมีอาการหายใจเข้าลึกๆ เป็นเสียง วู๊ป (Whooping cough) สลับกันไปกับการไอ
เป็นชุดๆ จึงมีชื่อเรียกว่า “โรคไอกรน” บางครั้งอาการอาจจะเรื้อรังนานเป็นเวลา 2-3 เดือน
เกิดจากเชื้อแบคทีเรีย Bordetella pertussis (B. pertussis) เป็นเชื้อที่เพาะขึ้นใน Bordet
Gengau media ซึ่งเป็นเชื้อที่เพาะขึ้นได้ยาก จะพบเชื้อได้ในลาคอ ในส่วน nasopharynx ของผู้ป่วย
ในระยะ 1-2 อาทิตย์แรก ก่อนมีอาการ ไอเป็นแบบ paroxysmal
31. ระบาดวิทยา
ไอกรนเป็นโรคที่ติดต่อกันได้ง่ายจากการไอ จาม รดกันโดยตรง ผู้สัมผัสโรคที่ไม่มีภูมิคุ้มกันจะ
ติดเชื้อและเกิดโรคเกือบทุกราย โรคนี้พบได้บ่อยในเด็ก ส่วนใหญ่ติดเชื้อมาจากผู้ใหญ่ในครอบครัว ซึ่งมีการติด
เชื้อแต่ไม่มีอาการ (carrier) หรือมีอาการไม่มาก โรคไอกรนเป็นได้กับทารกตั้งแต่เดือนแรก ทั้งนี้ เนื่องจาก
ภูมิคุ้มกันจากแม่ผ่านมายังลูกไม่ได้หรือได้น้อยมาก ในเด็กเล็กอาการจะรุนแรงมากและมีอัตราตายสูง ส่วนใหญ่
ของผู้ที่มีอาการรุนแรงและเสียชีวิต เป็นเด็กอายุต่ากว่า 1 ปีและเป็นเด็กที่ไม่เคยได้รับวัคซีนมาก่อน โดยทั่วไป
แล้ว โรคนี้เป็นได้ทุกอายุ ถ้าไม่มีภูมิคุ้มกัน แต่ในวัยหนุ่มสาว หรือผู้ใหญ่อาจไม่มีอาการ หรือไม่มีอาการแบบ
ไอกรน ส่วนใหญ่จึงไม่ได้รับการวินิจฉัยว่าเป็นโรคไอกรน
ระยะฟักตัวของโรคประมาณ 6-20 วัน ที่พบบ่อย 7-10 วัน ถ้าสัมผัสโรคมาเกิน 3 สัปดาห์แล้วไม่มีอาการ
แสดงว่าไม่ติดโรค
32. อาการและอาการแสดง
อาการของโรคแบ่งได้เป็น 3 ระยะ ดังนี้
1) ระยะแรก เด็กจะเริ่มมีอาการ มีน้ามูก และไอ เหมือนอาการเริ่มแรกของโรคหวัดธรรมดา อาจมีไข้
ต่าๆ ตาแดง น้าตาไหล ระยะนี้เรียกว่า Catarrhal stage จะเป็นอยู่ประมาณ 1-2 สัปดาห์ ระยะนี้ส่วนใหญ่ยัง
วินิจฉัยโรคไอกรนไม่ได้ แต่มีข้อสังเกตว่าไอนานเกิน 10 วัน เป็นแบบไอแห้งๆ
2) Paroxysmal stage ระยะนี้มีอาการไอเป็นชุดๆ เมื่อเข้าสู่สัปดาห์ที่ 3 ไม่มีเสมหะ จะเริ่มมีลักษณะ
ของไอกรน คือ มี อาการไอถี่ๆ ติดกันเป็นชุด 5-10 ครั้ง ตามด้วยการหายใจเข้าอย่างแรงจนเกิดเสียง วู๊ป (whoop) ซึ่ง
เป็นเสียงการดูดลมเข้าอย่างแรง ในช่วงที่ไอผู้ป่วยจะมีหน้าตาแดง น้ามูก น้าตาไหล ตาถลน ลิ้นจุกปาก เส้นเลือดที่คอโป่ง
พอง การไอเป็นกลไกที่จะขับเสมหะที่เหนียวข้นในทางเดินหายใจออกมา ผู้ป่วยจึงจะไอติดต่อกันไปเรื่อยๆ จนกว่าจะ
สามารถขับเสมหะที่เหนียวออกมาได้ 3) ระยะ ฟื้นตัว (Convalescent stage) กินเวลา 2-3 สัปดาห์ อาการไอเป็น
ชุดๆ จะค่อยๆ ลดลงทั้งความรุนแรงของการไอและจานวนครั้ง แต่จะยังมีอาการไอหลายสัปดาห์ ระยะของโรคทั้งหมดถ้า
ไม่มีโรคแทรกซ้อนจะใช้เวลาประมาณ 6-10 สัปดาห์
33. โรคแทรกซ้อน
1. โรคแทรกซ้อนทางระบบทางเดินหายใจ ที่พบบ่อย คือ ปอดอักเสบ ซึ่งเป็นสาเหตุของ
การตายที่สาคัญของโรคไอกรนในเด็กเล็ก โรคในปอดที่อาจพบได้อีกจะเกิดจากการมีเสมหะเหนียวไปอุด
ในหลอดลมและถุงลม ทาให้เกิด atelectasis
2. จากการไอมากๆ ทาให้มีเลือดออกในเยื่อบุตา (Subconjunctival hemorrhage)
มี petechiae ที่หน้า และในสมอง
3. ระบบประสาท อาจมีอาการชัก พบบ่อยในเด็กเล็ก เนื่องจากขาดเลือดไปเลี้ยงสมอง
ในขณะที่ไอถี่ๆ และอาการชักอาจเกิดจากมีเลือดออกในสมอง
34. การวินิจฉัยโรค
อาศัยอาการทางคลินิกที่มีลักษณะอาการไอเป็นชุดๆ มีเสียงวู๊ป ร่วมกับการตรวจเลือด พบมีเม็ด
เลือดขาวสูงเกินปกติ และมี lymphocytosis แต่เนื่องจากอาการไอแบบนี้อาจเกิดจากเชื้อ B. parapertussis,
Clamydia trachomatis และ adenoviruses การวินิจฉัยที่แน่นอนจึงต้องทาการเพาะเชื้อ B. pertussis
จาก nasopharyngeal swab หรือดูดเอา nasopharyngeal mucus มาเพาะบน Bordet Gengau
media ส่วนใหญ่จะตรวจพบเชื้อได้ในระยะ Catarrhal stage และในสัปดาห์แรกที่เริ่มมีอาการไอแบบ
paroxysmal ภายหลังจากเริ่มมีอาการ 4 สัปดาห์ มักจะตรวจไม่พบเชื้อ
35. การรักษา
เนื่องจากเชื้อ B. pertussis จะมีอยู่ในลาคอของผู้ป่วยในช่วงระยะแรก (Catarrhal
stage) ดังนั้นถ้าให้ยาปฎิชีวนะที่ได้ผลเฉพาะคือ erythromycin ในขนาด 50 มก./กก./วัน เป็นระยะเวลา
14 วัน ในระยะนี้จะช่วยให้ความรุนแรงของโรคลดลงได้ แต่ถ้าพบผู้ป่วยระยะที่มีการไอเป็นชุดๆ แล้วการให้
ยาจะไม่สามารถเปลี่ยนแปลงความรุนแรงของโรคได้ แต่จะสามารถฆ่าเชื้อโรคที่อาจจะยังมีอยู่ให้หมดไปได้ใน
ระยะ 3-4 วัน เป็นการลดการแพร่กระจายของเชื้อได้
การ รักษาตามอาการให้เด็กได้พักผ่อน ดื่มน้าอุ่น อยู่ในห้องที่มีอากาศถ่ายเทได้ดี หลีกเลี่ยง
สาเหตุที่จะทาให้เด็กไอมากขึ้น เช่น การออกแรง ฝุ่นละออง ควันไฟ ควันบุหรี่ อากาศที่ร้อนหรือเย็นจัด
เกินไป
36. Diagnosis, Treatment, and Prevention
การวินิจฉัยโรคกระเพาะปัสสาวะที่ไม่ซับซ้อน (การติดเชื้อในกระเพาะปัสสาวะ) และ pyelonephritis
(ไตการติดเชื้อ) โดยปกติแล้วจะทาได้ง่ายขึ้นจากการนาเสนอทางคลินิกในขณะที่การวินิจฉัยในผู้ป่วยที่มี
อาการ UTI ซับซ้อนมักจะมีความซับซ้อนมากขึ้น กระเพาะปัสสาวะอักเสบที่ไม่ซับซ้อนมักจะถูกประจักษ์
โดยการหายใจผิดปกติความถี่และ / หรือความเร่งด่วนโดยไม่ต้องมีไข้และ pyelonephritis มักจะเป็น
ที่ประจักษ์โดยมีไข้และอาการปวดหลัง / อ่อนโยนมุมอ่อนโยน
Diagnosis, Treatment, and Prevention
37. 38. Burkholderia
Burkholderia เป็นกลุ่มของ Proteobacteria ที่มีเชื้อโรครวมถึง Burkholderia cepacia complex ซึ่งทา
ร้ายมนุษย์และ Burkholderia mallei ซึ่งเป็นต้นเหตุของโรคที่เกิดจาก ม้า และสัตว์ที่เกี่ยวข้อง Burkholderia
pseudomallei สาเหตุของ melioidosis ; และ Burkholderia cepacia เป็นเชื้อที่สาคัญในการติดเชื้อใน
ปอดในคนที่เป็น โรคปอดเรื้อรัง ( cystic fibrosis , CF)
39. Burkholderia
กลุ่ม Burkholderia หมายถึงกลุ่มของ Gram-negative ที่มีอยู่ ทั่วไปแพร่หลาย แบคทีเรีย รูปแท่งซึ่งมี
ลักษณะ เป็น โมเลกุล เดียวหรือหลายขั้วยกเว้น Burkholderia mallei ซึ่งเป็น โมเลกุลที่ไม่ใช่ บิ วทิล สมาชิกที่เป็น
ของสกุลไม่ได้ผลิตปลอกหรือ prosthecae และสามารถใช้ โพลีเบต้า - ไฮดรอกซีบิวเทท (PHB) เพื่อการเจริญเติบโต
ได้ สกุลรวมทั้ง เชื้อโรค จากสัตว์และพืชรวมทั้งสายพันธุ์ที่มีความสาคัญต่อสิ่งแวดล้อม โดยเฉพาะอย่างยิ่ง B.
xenovorans (ก่อนหน้านี้ชื่อ Pseudomonas cepacia แล้ว B. cepacia และ B. fungorum ) มีชื่อเสียงในด้าน
catalase positive (มีผลต่อผู้ป่วยที่เป็น โรค granulomatous เรื้อรัง ) และความสามารถในการย่อยสลายสาร
กาจัดศัตรูพืชคลอโรนิกและ polyplorylated biphenyls ( PCBs ) โครงสราง RNA แบบอนุรักษ RNA anti-
hemB RNA พบไดในแบคทีเรียที่พบในสกุลนี้ [2]
เนื่องจากความต้านทานยาปฏิชีวนะและอัตราการเสียชีวิตสูงจากโรคที่เกี่ยวข้องของพวกเขา B. mallei และ B.
pseudomallei ถือเป็นตัวแทน สงครามทางชีวภาพที่ มีศักยภาพซึ่งมีเป้าหมายสาหรับปศุสัตว์และมนุษย์
40. Pseudomonas เป็น สกุล Gram-negative
Gammaproteobacteria ซึ่งเป็นตระกูล Pseudomonadaceae
และมี 191 สายพันธุ์ที่ถูกต้อง สมาชิกของสกุลแสดงให้เห็นถึงความ
หลากหลายของการ เผาผลาญอาหาร และทาให้สามารถตั้งอาณา
นิคมช่วงกว้างได้ ความสะดวกในการเพาะเลี้ยง ในหลอดทดลอง และ
ความพร้อมในการเพิ่มจานวนสายพันธุ์ จีโนม ของสายพันธุ์
Pseudomonas ทาให้พันธุ์พืชเป็นจุดสนใจที่ยอดเยี่ยมสาหรับการ
วิจัยทางวิทยาศาสตร์ สายพันธุ์ที่ได้รับการศึกษาที่ดีที่สุด ได้แก่
P. aeruginosa ในฐานะที่เป็นเชื้อก่อโรคในมนุษย์ เชื้อโรคพืช
P. syringae แบคทีเรียในดิน P. putida และ P. fluorescens ที่
ส่งเสริมการเจริญเติบโตของพืช
Pseudomonas
41. Pseudomonas Aeruginosa
การติดเชื้อ Pseudomonas Aeruginosa ชนิดรุนแรงมักเกิดขึ้นภายในโรงพยาบาล และผู้ป่วยอาจมีการติด
เชื้อระดับไม่รุนแรงในสภาพแวดล้อมอื่นๆ ได้ ในสหรัฐอเมริกามีการคาดการณ์ว่ามีการติดเชื้อ
Pseudomonas Aeruginosa ในสถานพยาบาลมากถึง 51,000 รายต่อปี หรือคิดเป็น 8% ของการติด
เชื้อในสถานพยาบาลทั้งหมด
42. การติดต่อและความเสี่ยงในการติดเชื้อ Pseudomonas Aeruginosa
เชื้อ Pseudomonas Aeruginosa ภายในโรงพยาบาลสามารถแพร่ได้ผ่านความไม่สะอาด เช่น บุคลากรทาง
การแพทย์ไม่ล้างมือ หรือผ่านทางการปนเปื้อนของอุปกรณ์ทางการแพทย์ที่ไม่ได้รับการฆ่าเชื้ออย่างเต็มที่
การติดเชื้อเชื้อ Pseudomonas Aeruginosa ภายในโรงพยาบาลที่พบว่าที่สุด คือการติดเชื้อใน
กระแสเลือด ภาวะปอดติดเชื้อ การติดเชื้อในทางเดินปัสสาวะและการติดเชื้อบริเวณแผลผ่าตัด การติดเชื้อเหล่านี้
มักส่งผลกระทบต่อผู้ที่กาลังป่วยอยู่ในโรงพยาบาลโดยเฉพาะในกลุ่มที่มีภูมิคุ้มกันต่อจากโรคหรือกการรักษาระยะ
ยาวขณะรับการรักษาในโรงพยาบาล คุณจะมีความเสี่ยงในการติดเชื้อ Pseudomonas Aeruginosa ที่รุนแรง
และอาจเป็นอันตรายถึงชีวิตหากคุณมีแผลผ่าตัด แผลไฟไหม้ หรือมีการใช้ช่วยเครื่องหายใจและอุปกรณ์อื่น ๆ
เช่น สายสวนปัสสาวะหรือสายให้น้าเกลือ การสัมผัสกับน้าที่มีการปนเปื้อนสามารถทาให้เกิดการติดเชื้อ
Pseudomonas Aeruginosa ชนิดไม่รุนแรงในคนที่สบายดีที่ไม่ได้อาศัยอยู่ภายในสถานพยาบาลได้
ตัวอย่างเช่น น้าในสระว่ายน้าหรืออ่างน้าร้อนที่ไม่ได้รับการฆ่าเชื้อด้วยคลอรีนที่มากพอสามารถทาให้
เกิดการติดเชื้อ Pseudomonas Aeruginosa ที่หู (พบบ่อยในเด็ก) และผื่นที่ผิวหนังได้ นอกจากนั้นยังอาจทา
ให้เกิดการติดเชื้อที่ตาในกลุ่มที่มีการใส่ Contact lens เป็นเวลานาน
43. 44. การรักษาการติดเชื้อ Pseudomonas Aeruginosa
การติดเชื้อ Pseudomonas Aeruginosa ที่ไม่รุนแรงผ่านทางน้าสามารถรักษาได้ไม่ยากด้วยยา
ปฏิชีวนะบางชนิด ในขณะที่การรักษาการติดเชื้อ Pseudomonas Aeruginosa ที่รุนแรงภายใน
โรงพยาบาลเป็นเรื่องที่ยากกว่า เนื่องจากบางสายพันธุ์มีการดื้อต่อยาหลายชนิด เช่น
Aminoglycosides
Cephalosporins
Fluoroquinolones
Carbapenems (ยาปฏิชีวนะที่ใช้เป็นตัวสุดท้าย)
45. moraxella
Moraxella เป็น เชื้อแบคทีเรีย Gram-negative ในครอบครัว Victor Morax สิ่งมีชีวิตเหล่านี้ ได้แก่
แท่ง สั้น coccobacilli หรือในกรณีของ Moraxella catarrhalis diplococci ในลักษณะทางสัณฐาน
วิทยาโดยมีสมบัติที่ทาให้เกิด asaccharolytic oxidase -positive และ catalase -positive M.
catarrhalis เป็นสายพันธุ์ที่สาคัญที่สุดในสายพันธุ์นี้
46. moraxella
สิ่งมีชีวิตเหล่านี้เป็น commensals ของพื้นผิว mucosal และบางครั้งทาให้เกิดการ ติดเชื้อฉวยโอกาส
M. catarrhalis มักอาศัยในระบบทางเดินหายใจ แต่สามารถเข้าถึง ระบบทางเดินหายใจส่วนล่าง ในผู้ป่วยโรค
เรื้อรังที่หน้าอกหรือป้องกันผู้บุกรุกที่เป็นอันตรายทาให้เกิด โรคหลอดลมอักเสบ และ โรคปอดบวม ตัวอย่างเช่น
มันทาให้เกิดสัดส่วนที่สาคัญของการติดเชื้อทางเดินหายใจที่ต่ากว่าในผู้ป่วยสูงอายุที่มี ปอดอุดกั้นเรื้อรัง และ
หลอดลมอักเสบเรื้อรัง นอกจากนี้ยังเป็นหนึ่งในสาเหตุสาคัญของ โรคหูน้าหนวก และ โรคไซนัสอักเสบ ทาให้
เกิดอาการคล้ายกับ Haemophilus influenzae แม้ว่าจะมี ความรุนแรง น้อยกว่ามากก็ตาม แตกต่างจาก
Neisseria meningitidis ซึ่งเป็นสัณฐานทางสัณฐานวิทยาของ M. catarrhalis แทบจะไม่เคยเป็นสาเหตุของ
แบคทีเรีย หรือ เยื่อหุ้มสมองอักเสบ
Moraxella lacunata เป็นหนึ่งในสาเหตุของการเกิด blepharoconjunctivitis ในคน
47. Moraxella bovis เป็นสาเหตุของ การติดเชื้อแบคทีเรียที่ ทาให้เกิด โรคตาแดง ที่เรียกว่า colloquially
ในสหราชอาณาจักรเป็น New Forest eye ในฐานะที่เป็น aerobe ที่เข้มงวด M. bovis จะถูกกักขังไว้
ที่กระจกตาและเยื่อบุลูกตาซึ่งจะส่งผลให้มีการอักเสบเรื้อรังที่ไม่สามารถจากัดตัวได้เองแผลพุพองและ การ
แตกของกระจกตา เป็นโรคที่พบได้บ่อยและติดเชื้อวัวเท่านั้น การรักษาคือการใช้ทั้งแบบ subconjunctival
injection ของ tetracycline หรือการใช้ยา cloxacillin เฉพาะที่มีประสิทธิผลมากขึ้น แบคทีเรียสามารถ
แพร่กระจายโดยแมลงวันดังนั้นการควบคุมแมลงวันอาจมีความจาเป็นในฟาร์มตลอดฤดูร้อน การแตกออก
ของตาเป็นเรื่องที่รุนแรงมากขึ้น
moraxella
48. Acinetobacter
เชื้อในกลุ่ม Acinetobacter spp. เป็นเชื่อแบคทีเรียแกรมลบ (gram-negative bacteria)
ทรงแท่ง ที่มีความสาคัญมากขึ้นในฐานะที่เป็นเชื้อก่อโรคในโรงพยาบาลที่พบได้บ่อยขึ้น และมักเป็นเชื้อที่ดื้อ
ต่อยาปฏิชีวนะหลายชนิด Acinetobacter spp. เป็นสาเหตุของ โรคปอดบวม (pneumonia) ชนิด
ventilator-associated ที่พบบ่อยที่สุดในหอผู้ป่วยหนัก (Intensive Care Unit, ICU;
Intermediate Care Unit) ของโรงพยาบาลรามาธิบดี ในพ.ศ. 2542 นอกจากนี้ยังมีรายงานการพบ
เชื้อนี้มากขึ้นในหลายๆ ประเทศ โดยส่วนใหญ่เป็นการติดเชื้อในโรงพยาบาล แม้ว่าจะมีรายงานการติดเชื้อ
Acinatobacter จากชุมชน แต่ก็ไม่มากนักเมื่อเทียบกับการติดเชื้อในโรงพยาบาล
ความสาคัญอีกประการหนึ่งของ Acinetobacter spp. คือ เชื้อเหล่านี้มักจะดื้อต่อยาปฏิชีวนะ
พร้อมๆ กันหลายชนิด โดยเฉพาะอย่างยิ่งการดื้อต่อยาในกลุ่ม Carbapenems โดยเชื้อที่ดื้อต่อ
Carbapenems มักจะดื้อต่อยาปฏิชีวนะหลายชนิดในเวลาเดียวกัน ทาให้มีความยากลาบากในการ
เลือกใช้ยาปฏิชีวนะในการรักษาภาวะติดเชื้อ Acinetobacter spp
49. Acinetobacter
เชื้อในสกุล Acinetobacter spp. มีลักษณะสาคัญคือเป็นแบบทีเรียรูปร่างกลม-แท่ง ประเภทแกรมลบที่ไม่
เคลื่อนไหว (non-motile Gram-negative coccobacilli) ซึ่งบางครั้งอาจติดสีคล้ายแบคทีเรียแกรมบวก
ได้ รูปร่างของเชื้ออาจเป็นได้ทั้งรูปร่างแบบกลมหรือแบบแท่ง แต่มักจะพบแบบกลมในอาหารเลื้ยงเชื้อแบบ
เหลว และในช่วงแรกของการเจริญเติบโต นอกจากนี้อาจยังมีรูปร่างที่แตกต่างกันออกไป ทาให้สามารถ
จาแนกเชื้อชนิดนี้ออกจากเชื้ออื่นๆที่ก่อโรคในสิ่งส่งตรวจได้ยาก
การเจริญเติบโตของเชื้อนี้ เป็นแบบอาศัยออกซิเจนเท่านั้น และให้ผลบวกกับปฏิกิริยากับเอนไซม์คาตาเลส
(catalase) กับผลลบกับปฏิกิริยากับเอนไซม์ออกซิเดส (oxidase) มีสัดส่วนของเบสกัวนีน (guanine)
รวมกับเบสไซโตซีน (cytosine) ในดีเอ็นเอ หรือค่า G+C content ระหว่างร้อยละ 39 ถึง 4
50. Francisella tularensis เป็นเชื้อที่ก่อให้เกิดโรค ได้แก่ กาม แบคทีเรีย
ก้านรูปแท่ง ( Gram-negative coccobacillus ) ซึ่งเป็น แบคทีเรีย aerobe [1] เป็นสปอร์ที่ไม่ก่อตัวขึ้น
ไม่ใช่ตัวกระตุ้น และเป็นสาเหตุของ โรคไข้เหลือง ซึ่งเป็นรูปแบบของ pneumonic ซึ่งมักเป็นอันตรายถึงตายโดย
ไม่ได้รับการรักษา เป็นแบคทีเรียภายในเซลล์ ที่มีความซับซ้อนซึ่งจาเป็นต้องใช้ cysteine เพื่อการเจริญเติบโต
เนืองจากเชื้อโรคต่าแพร่กระจายได้ง่ายโดยละอองลอยและมี ความรุนแรง สูง
bioterrorism เช่น Yersinia pestis , Bacillus anthracis และไวรัส อีโบลา เมื่อพบในธรรมชาติ
Franciesella tularensis สามารถอยู่รอดได้เป็นเวลาหลายสัปดาห์ที่อุณหภูมิต่าในซากสัตว์ดินและน้า ใน
ห้องปฏิบัติการ Francisella tularensis จะปรากฏเป็นแท่งเล็ก ๆ (0.2 โดย 0.2 μm) และเติบโตได้ดีที่สุดที่
อุณหภูมิ 35-37 องศาเซลเซียส
Francisella tularensis
51. Francisella tularensis
ชนิดย่อย F. t. tularensis (หรือชนิด A) พบมากใน ทวีปอเมริกาเหนือ เป็นโรคที่รุนแรงที่สุดในสี่ชนิดย่อยที่รู้จักและ
เกี่ยวข้องกับการติดเชื้อในปอดที่ตายแล้ว ซึ่งรวมถึงสายพันธุ์หลักของห้องทดลอง A, SCHUS4
กลุ่มย่อย F. t. holarctica (เรียกอีกอย่างว่า biovar F. t. palearctica หรือชนิด B) พบมากใน ยุโรป และ เอเชีย
แต่ไม่ค่อยนาไปสู่โรคร้ายแรง สายพันธุ์ วัคซีนที่ ถ่ายทอดสดที่อ่อนแอของกลุ่มย่อย F. t holarctica ได้รับการอธิบายแม้ว่าจะยัง
ไม่ได้รับอนุญาตอย่างเต็มที่โดย องค์การอาหารและยา เป็นวัคซีน กลุ่มย่อยนี้ขาดกิจกรรม cytrelase และความสามารถในการ
ผลิตกรดจากน้าตาลกลูโคสของ Biovar F. t palearctica
กลุ่มย่อย F. t. novicida (จัดก่อนหน้านี้เป็น F. novicida [8] ) มีลักษณะเป็นสายพันธุ์ nonvirulent ค่อนข้าง; มี
เพียงสองกรณีโรคโลหิตจางในทวีปอเมริกาเหนือมีสาเหตุมาจาก F. t novicida และเหล่านี้เป็นเฉพาะในบุคคลที่ มีภูมิคุ้มกัน
บกพร่อง อย่างรุนแรง
กลุ่มย่อย F. t. mediasiatica พบมากที่สุดใน เอเชียกลาง ปัจจุบันมีเพียงเล็กน้อยที่รู้จักเกี่ยวกับเรื่องย่อยนี้หรือ
ความสามารถในการติดเชื้อของมนุษย์
52. F. tularensis ได้รับการรายงานใน นก สัตว์เลื้อยคลาน ปลา สัตว์ไม่มีกระดูกสันหลัง และ สัตว์เลี้ยงลูกด้วยนม รวมทั้ง
มนุษย์ อย่างไรก็ตามเรื่องนี้ไม่ได้แสดงให้เห็นกรณีของ tularemia ใด ๆ ที่จะเริ่มต้นโดยการส่งผ่านจากมนุษย์สู่คน โรคนี้
เกิดจากการติดต่อกับสัตว์หรือ พาหะที่ ติดเชื้อเช่น เห็บ ยุง และ กวางชนิดกวาง อ่างเก็บน้าที่มีความสาคัญสามารถรวมถึง
lagomorphs (เช่นกระต่าย) หนู galliform นก และ กวาง
การติดเชื้อ F. tularensis สามารถเกิดขึ้นได้หลายเส้นทางการเข้ารับการรักษาโดยการผ่านเลือดและระบบทางเดินหายใจ
ที่พบมากที่สุดเกิดขึ้นผ่านการสัมผัสกับผิวหนังทาให้เกิดรูปแบบของโรคกระเพาะอาหารลาไส้ใหญ่ การสูดดมแบคทีเรีย -
โดยเฉพาะ biovar F. t tularensis นาไปสู่ ภาวะ โลหิตจาง จากโรค ลม ปอด ในขณะที่รูปแบบของโรคในเม็ดเลือดแดง
ในปอดและทรวงอกเป็นเรื่องปกติมากขึ้นมีการอธิบายถึงวิธีการฉีดวัคซีนอื่น ๆ และรวมถึงการติดเชื้อที่ ช่องปากอักเสบ
เนื่องจากการบริโภคอาหารที่ปนเปื้อนและการติดเชื้อในตาซึ่งเกิดจากการฉีดวัคซีนที่ตา
53. โรคทูลารีเมีย (Tularemia) Bureau of Epidemiology, DDC, MPH
นายสัตว์แพทย์ธีรศักดิ์ ชักนา
ลักษณะของโรค
โรคทูลารีเมีย หรือโรคไข้กระต่าย (Rabbit Fever) เป็นโรคติดต่อจากสัตว์ถึงคน ที่มีอันตรายสูงโรคหนึ่งเนื่องจากสามารถ
ติดต่อทางละอองฝอย (Aerosol) ได้ และสามารถใช้เป็นอาวุธชีวภาพที่จัดอยู่ในกลุ่ม A ประเทศ สหรัฐอเมริกาตั้งแต่ต้นปี พ.ศ.
2545 จนถึงขณะนี้ พบว่ามีรายงานผู้ป่วยมากกว่า 200 ราย
ระบาดวิทยา
โรคนี้เกิดในสหภาพโซเวียต เอเซียไมเนอร์ ญี่ปุ่น สหรัฐอเมริกา แคนาดา และยุโรป ยกเว้นคาบสมุทรไอเบอเรียน (Iberian
Peninsula) และเกาะอังกฤษ
เชื้อก่อโรค
โรคนี้เกิดจากเชื้อแบคทีเรีย ชื่อ Francisella tularensis มีลักษณะเป็นค็อกโคบาซิลไล ไม่เคลื่อนที่ ไม่สร้างสปอร์ มีแคปซูล
แบคทีเรียนี้มี 4 types โดย Type A มีความรุนแรงที่สุด
สัตว์รังโรค และแมลงนาโรค
สัตว์รังโรคอยู่ในสัตว์ป่าที่เลี้ยงลูกด้วยนมกว่า 100 ชนิด รวมทั้ง สัตว์ฟันแทะ เช่น กระต่าย หนู กระรอก กวาง แพรีด๊อก
(Parrie dog) และสามารถติดต่อมายังสัตว์เลี้ยงจาพวกวัว ควาย แกะ และแมว ได้ โดยมีเหลือบ เห็บ หมัด หรือยุง เป็น
แมลงนาโรค
54. วิธีการติดต่อ
โรคนี้ติดต่อมายังคนโดยถูกแมลงพาหะที่กัดเลือดสัตว์ที่ติดเชื้อนี้กัด หรือติดโดยสัมผัสกับเลือด สารคัดหลั่ง (Secretion) ของสัตว์ที่
ป่วยด้วยโรคนี้ เข้าทางบาดแผล เยือเมือก หรือรอยถลอก ขีดข่วน หรือถูกสัตว์ป่วยกัดโดยตรง การหายใจ หรือกินอาหารหรือน้า
ที่มีเชื้อโรคปนได้เชื้อก็สามารถทาให้ติดเชื้อได้ ไม่มีรายงานการติดต่อระหว่างคนสู่คน
ระยะฟักตัวของโรค 1-14 วัน แต่ทั่วๆ ไป 3-5 วัน
อาการในคน
ลักษณะของโรคทูลารีเมีย ในคนมี 2 รูปแบบขึ้นอยู่ช่องทางที่เชื้อเข้าสู่ร่างกาย คือทางผิวหนัง และทางการหายใจ หากเชื้อเข้าทาง
ผิวหนังจะเกิดบาดแผล ต่อมน้าเหลืองบวมโตตรงที่รับเชื้อหากเชื้อเข้าสู่ร่างกายโดยการหายใจผู้ติดเชื้อจะเป็นไข้แบบไทฟอยด์
(typhoidal tularemia) คือมีไข้ หนาวสั่น โลหิตเป็นพิษ ปวดศีรษะ ท้องเสีย ปวดกล้ามเนื้อ ปวดข้อ ไอแห้งๆ และอ่อนเพลีย
หากผู้ป่วยมีอาการปอดบวมร่วมด้วยจะเจ็บหน้าอก มีเสมหะเป็นเลือด อึดอัด หายใจไม่สะดวก จนอาจหยุดหายใจ ลักษณะปอด
บวมจากการตรวจทางรังสีทรวงอก อัตราตายของโรคแบบไข้ประมาณร้อยละ 35
การรักษา
รักษาโดยการใช้ยาปฏิชีวนะจาพวกสเตร็พโตไมซิน ฉีดเข้ากล้ามเนื้อในปริมาณ 30 มิลลิกรัมต่อน้าหนักตัว 1 กิโลกรัม หรืออาจใช้
ยาเจนตาไมซิน ปริมาณ 3-5 มิลลิกรัมต่อน้าหนักตัว 1 กิโลกรัมต่อวัน ติดต่อกัน 10-14 วัน ยาเตตระไซคลีน และครอแรมเฟนิ
คอลก็ใช้ได้ผลเช่นเดียวกัน แต่ผู้ติดเชื้อมักมีอาการไข้กลับค่อนข้างสูง
55. Legionella pneumophila เป็นเชื้อแบคทีเรียแกรมลบที่เป็น แบคทีเรียแกรมลบชนิด Legionella , บางชนิด
แอโรบิก , pleomorphic , flagellated , nonspore-forming L. pneumophila เป็น เชื้อแบคทีเรียที่
ก่อให้เกิดโรคหลักในมนุษย์ในกลุ่มนี้และเป็นสาเหตุสาคัญของ โรค Legionnaires ' หรือเรียกอีกอย่างว่า
legionellosis
Legionella pneumophila
56. Legionnaire DiseaseBureau of Epidemiology, DDC, MPH
ลักษณะโรค
โรคลีเจียนเนลโลสิส (Legionellosis) เป็นโรคติดต่อที่เกิดจากเชื้อแบคทีเรียชื่อ Legionella pneumophila ลักษณะโรคมี 2
แบบ คือ ชนิดรุนแรงเรียกโรคปอดอักเสบลีเจียนแนร์ (Legionnaires' disease) และชนิดไม่รุนแรงเรียกโรคไข้ปอนเตียก
(Pontiac fever)
สาเหตุ
เกิดจากเชื้อแบคทีเรีย Legionella ที่ตรวจพบแล้วประมาณ 43 species 65 serogroups ที่พบก่อให้เกิดโรคในคนบ่อยที่สุดคือ
Legionella pneumophila ซึ่งตรวจพบแล้ว 18 serogroups เชื้อ Legionlla พบได้ทั่วไปในแหล่งน้าที่มีอุณหภูมิ 32-45 ซ
สามารถมีชีวิตอยู่ได้นานหลายเดือนในสิ่งแวดล้อมที่มีความชื้นสูง และแบ่งตัวในที่ที่มีสาหร่ายและอินทรีย์วัตถุ
วิธีการติดต่อ
โดยการสูดหายใจเอาเชื้อที่ปนเปื้อนอยู่ในละอองฝอยของน้า เช่น น้าจากหอผึ่งเย็นความร้อน(cooling towers) ของระบบปรับ
อากาศ ฝักบัวอาบน้า อ่างน้าวน เครื่องมือช่วยหายใจ น้าพุสาหรับตกแต่งอาคารสถานที่ต่างๆ การแพร่เชื้อจากคนไปสู่คนยังไม่มี
ปรากฎ
ระยะฟักตัว
โรคลีเจียนแนร์ส่วนใหญ่จะปรากฎอาการภายใน 5-6 วันหลังได้รับเชื้อ แต่อาจอยู่ในช่วง 2-10 วัน
โรคไข้ปอนเตียกมักจะมีอาการภายใน 24-48 ชั่วโมงหลังได้รับเชื้อ แต่อาจอยู่ในช่วง 5-66 ชั่วโมง
57. ระยะติดต่อ
ยังไม่พบการแพร่เชื้อระหว่างคนสู่คนดังนั้นคนจึงไม่เป็นพาหะของโรค มีการตรวจเลือดของผู้ป่วยภายหลังป่วย
หลายปีพบแอนติบอดีต่อ Legionella ซึ่งบ่งชี้ว่าเคยป่วยมาแล้วไม่ใช่กาลังป่วย
อาการและอาการแสดง
มีอาการคล้ายไข้หวัดใหญ่ (flu-like illness) เริ่มด้วย ปวดศรีษะ ปวดกล้ามเนื้อ ตามด้วยมีไข้สูง (39-40o
ซ) หนาวสั่น เบื่ออาหาร คลื่นไส้อาเจียน อาจมีอุจจาระร่วง ไอแห้งๆ ในกรณีที่เป็นไข้ปอนเตียกมักจะหาย
ภายใน 2-5 วัน แม้จะไม่ได้รับการรักษา ส่วนโรคลีเจียนแนร์มักจะมีปอดอักเสบและลามไปที่ปอดทั้งสองข้าง ทา
ให้การหายใจล้มเหลว มีอัตราตายสูง
การวินิจฉัยแยกโรค
ถ้าต้องการวินิจฉัยแยกจากโรคปอดอักเสบจากเชื้ออื่นๆต้องตรวจยืนยันทางห้องปฏิบัติการโดยการเพาะแยกเชื้อ
จากเสมหะ น้าจากโพรงเยื่อหุ้มปอด หลอดลม หลอดคอ หรือ ตรวจหาแอนติบอดีในเลือด การเพาะแยกเชื้อเป็น
การตรวจที่สาคัญถือเป็น gold standard
58. ระบาดวิทยา
มีบันทึกการพบผู้ป่วยรายแรกใน พ.ศ. 2490 และการระบาดครั้งแรกใน พ.ศ. 2500 ที่รัฐมินนิโซตา มีการระบาดครั้งใหญ่ของโรค
ปอดอักเสบในหมู่ผู้ร่วมประชุมสมาคม "สหายสงคราม" (American Legion Convention) ที่เมืองฟิลาเดลเฟีย สหรัฐอเมริกา
ใน พ.ศ. 2519 มีผู้ป่วย 182 ราย เสียชีวิต 29 ราย อีก 6 เดือนต่อมา McDade JE และคณะ จึงได้พบเชื้อแบคทีเรียที่เป็น
สาเหตุจากปอดของผู้เสียชีวิต จึงเป็นที่มาของชื่อ "โรค Legionella pneumophila"
โรคลีเจียนแนร์เป็นโรคที่ต่างประเทศให้ความสนใจเนื่องจากมีอัตราป่วยตายสูงโดยเฉพาะประเทศ ในแถบยุโรปมีระบบเฝ้าระวังและ
มีคณะทางานสาหรับโรคนี้โดยเฉพาะเรียกว่า European working group for Legionella infections (EWGLI) อัตรา
ป่วยของโรคนี้โดยเฉลี่ยในยุโรปเท่ากับ 4.45/ล้านประชากร ในปี 2539
สาหรับประเทศไทยยังพบโรคนี้น้อย โดยมีรายงานผู้ป่วย 5 ราย รายแรกเป็นหญิงไทยอายุ 19 ปี รายงานโดย ศรีไสวและคณะ
ใน พ.ศ. 2527 ในปีเดียวกัน ตันไพจิตรและคณะรายงานผู้ป่วยอีก 3 ราย พ.ศ. 2529 ชุณหสวัสดิกุลและคณะ รายงานผู้ป่วย 1
รายเป็นชายจีนอายุ 78 ปี และในปี 2532 ชูโชติถาวรและคณะรายงานผู้ป่วยอีก 1 ราย เป็นหญิงจีนอายุ 39 ปี นอกจากนี้ยัง
ได้รับแจ้งเกี่ยวกับนักท่องเที่ยวต่างชาติที่ป่วยด้วยโรค Legionnaires หลังกลับจากเดินทางมาท่องเที่ยวในประเทศไทย ตั้งแต่ปี
พ.ศ. 2535 ต่อเนื่องจนถึง พ.ศ.2542 จานวน 12 ราย
มักพบในวัยกลางคน ผู้ที่มีภูมิคุ้มกันบกพร่อง ได้แก่ มะเร็ง ผู้ติดเชื้อเอดส์ที่มีอาการ ผู้ป่วยเอดส์ ผู้ป่วยโรคเรื้อรัง ได้แก่ เบาหวาน
โรคปอดเรื้อรัง โรคพิษสุราเรื้อรัง สูบบุหรี่จัด
59. การรักษา
ยาปฏิชีวนะที่ใช้รักษาคือ erythromycin ยาที่ใหม่กว่าคือ azithromycin และ clarithromycin ก็
ใช้ได้ผลเช่นกัน ในรายที่มีอาการรุนแรงยาที่ใช้เพิ่มคือ rifampin
การควบคุมผู้ป่วย ผู้สัมผัส และสิ่งแวดล้อม
รายงานการระบาด : เมื่อพบผู้ป่วยที่สงสัย (suspected case) หรือพบการป่วยเป็นกลุ่มก้อนให้รายงาน
สานักงานสาธารณสุขจังหวัดทันทีทางโทรศัพท์หรือโทรสาร แล้วส่ง รง.506 ไปตามลาดับขั้นของเครือข่าย
ระบาดวิทยา
การแยกผู้ป่วย : ไม่จาเป็น
การทาลายเชื้อ : ทาลายเชื้อในแหล่งที่สงสัยด้วยคลอรีนหรือน้าร้อนจัด
การกักกัน : ไม่จาเป็น
การให้ภูมิคุ้มกันแก่ผู้สัมผัส : ไม่มี
การสอบสวนผู้สัมผัสและแหล่งโรค : ค้นหาผู้ป่วยเพิ่มเติมจากสิ่งแวดล้อมหรือแหล่งโรคเดียวกัน
60. Coxiella burnetii เป็น แบคทีเรียที่ เป็น
สาเหตุของ แบคทีเรีย ภายใน และเป็นสาเหตุของ ไข้คิว
ชนิด Coxiella คล้าย morphologically Rickettsia
แต่มีความแตกต่างทางพันธุกรรมและความแตกต่างทาง
สรีรวิทยา C. burnetii เป็น แบคทีเรียแกรมลบที่ มี
ขนาดเล็กซึ่งทนต่อสภาวะแวดล้อมที่รุนแรงเช่นอุณหภูมิสูง
Coxiella burnetii
ความดันออสโมซิสและแสงอัลตราไวโอเลต ลักษณะเหล่านี้เป็นผลมาจากรูปแบบของเซลล์ขนาดเล็ก
รูปแบบของสิ่งมีชีวิตที่เป็นส่วนหนึ่งของวัฎจักรการพัฒนาแบบ biphasic ซึ่งรวมถึงรูปแบบของเซลล์
ขนาดใหญ่ที่มีการเผาผลาญอาหารและมีการลอกเลียนแบบมากขึ้น และสามารถทนต่อการเปลี่ยนแปลง
สภาพแวดล้อมอื่น ๆ ได้เช่นเดียวกับที่แสดงใน phagolysosome
61. โรคไข้คิว มีสาเหตุจากเชื้อแบคทีเรีย Coxiella burnetii พบได้ทั่วโลก ยกเว้นประเทศ
นิวซีแลนด์ โรคนี้ทาให้เกิดปัญหาของระบบสืบพันธุ์ในปศุสัตว์ และปัญหาของระบบ
ทางเดินหายใจอย่างรุนแรง และโรคตับในคน
โรคไข้คิว Q Fever
อาการของโรค : หนาวสั่น ปวดศีรษะ ไม่มีแรง ปวดกล้ามเนื้อ และเหงื่อออกมาก จากการตรวจเอ็กซเรย์อาจพบ
อาการปอดบวม อาการไอ มีเสมหะ เจ็บหน้าอกและอาการทางปอดไม่เด่นชัด ซึ่งสามารถเกิดได้ในผู้ที่มีโรคลิ้น
หัวใจอยู่เดิม ตรวจพบหน้าที่การทางานของตับผิดปกติ ตับอักเสบชนิดเฉียบพลันหรือเรื้อรัง ซึ่งอาจสับสนกับโรค
ตับอักเสบจากวัณโรคได้ ลักษณะของโรคไข้คิวเรื้อรังหลักๆ คือ เยื่อบุหัวใจอักเสบ
ระยะฟักตัวของโรค : ขึ้นอยู่กับจานวนเชื้อ ระยะฟักตัวโดยประมาณ 2 - 3 สัปดาห์ หรือพบในช่วง 3 - 30 วัน
62. การวินิจฉัยโรค : การตรวจวินิจฉัยทางห้องปฏิบัติการแสดงให้เห็นแอนติบอดีจาเพาะที่เพิ่มขึ้น ระหว่าง
ระยะเฉียบพลัน และระยะพักฟื้น โดยวิธี IndirectFluorescent (IF) หรือ Complement Fixation
test (CF)หรือโดยการตรวจ IgM โดยวิธี IF หรือ ELISA การวินิจฉัยจะใช้การเตรียมแอนติเจน 2
ระยะ คือ ระยะที่ 1 แทนสารก่อโรค และ ระยะที่ 2 เป็นชนิดที่สร้างขึ้นจากการตัดLPS ในห้องปฏิบัติการ
ในระยะเฉียบพลัน แอนติบอดีต่อแอนติเจนระยะที่ 2 จะมีระดับที่สูงกว่าแอนติบอดีระยะที่ 1 และในโรคเรื้อรัง
ผลจะกลับกัน ระดับไตเตอร์ของ
63. การรักษา : โรคชนิดเฉียบพลัน; ให้รับประทานยาเตตราซัยคลิน (Tetracyclines) (โดยเฉพาะ
Doxycycline) ทางปาก 14 - 21 วัน ยาด๊อกซีซัยคลิน (Doxycycline) และไฮดรอกซีคลอโรควีน
(Hydroxychloroquine) อาจช่วยป้องกันการเกิดโรคเยื่อบุหัวใจอักเสบในผู้ป่วยโรคไข้คิว และลิ้นหัวใจชนิด
เฉียบพลัน ยาควิโนโลน(Quinolones) ใช้ในการรักษาโรคไข้คิว (ยาเอ็นบี เตตราซัยคลิน (NB
Tetracycline) ไม่สามารถใช้ในเด็กที่อายุต่ากว่า 8 ปี) ในกรณีหญิงตั้งครรภ์ ยาโคไตรม๊อกซาโซล
(Cotrimoxazole) ใช้ได้ตลอดระยะตั้งครรภ์ โรคชนิดเรื้อรัง (โรคเยื่อบุหัวใจอักเสบ); ใช้ยาด๊อกซีซัยคลิน
(Doxycycline) ร่วมกับยาไฮดรอกซีคลอโรควีน(hydroxychloroquine) เป็นเวลา 18 - 36 เดือน หรือ
ใช้ยาด๊อกซีซัยคลิน (Doxycycline) ทานร่วมกับยาไรแฟมปิซิพิน (Rifampicin) เป็นเวลา 3 ปี หรือ ใช้
ยาด๊อกซีซัยคลิน (Doxycycline) ทานรวมกับยาควิโนโลน(Quinolone) การผ่าตัดเปลี่ยนลิ้นหัวใจที่ติดเชื้อ
เป็นสิ่งจาเป็นสาหรับผู้ป่วยบางราย เพื่อเหตุผลด้านการไหลเวียนโลหิต
64. 65. 66. ในกลุ่ม Bacteroides เชื้อ B.fragilis เป็นเชื้อที่พบมากที่สุดรองลงมาคือ B.thetaiotaomicron และกลุ่มอื่น ๆ
ในกลุ่ม B.fragilis ในบรรดาสายพันธุ์ Prevotella ที่เกี่ยวกับ น้าดี คนที่พบมากที่สุด ได้แก่
P.melaninogenica, P.oris และ P.buccae สายพันธุ์ Porphyromonas
ดูเหมือนจะทาให้เกิดโรคได้น้อยมากยกเว้นในการติดเชื้อทางทันตกรรม Fusobacterium nucleatum เป็นเชื้อ
Fusobacterium ที่พบบ่อยที่สุดในฐานะเชื้อก่อโรค แต่ F.necrophorum เป็นโรคร้ายแรงในบางครั้ง เหล่านี้มี
หลายสายพันธุ์อื่น ๆ ที่ไม่ค่อยหรือไม่เคยติดเชื้อมนุษย์
67. อาการทางคลินิก
Gram-negative anaerobic bacilli อาจทาให้เกิดการติดเชื้อที่ใดก็ได้ในร่างกาย ชนิดที่พบมากที่สุดคือ
ช่องปากและฟัน ช่องท้อง pleuropulmonary ภายในช่องท้องอวัยวะเพศหญิงและผิวหนังเนื้อเยื่ออ่อนและ
การติดเชื้อของกระดูก อาจมีบทบาทในกระบวนการทางพยาธิวิทยาที่หลากหลาย เช่น โรคปริทันต์และ
มะเร็งลาไส้ใหญ่ Bacteroides, Prevotella Porphyromonas และ Fusobacterium ผลิตเอนไซม์
(collagenase, neuraminidase, deoxyribonuclease, deoxyribonuclease [DNase],
heparinase และ proteinase)
อาจมีบทบาทในการเกิดโรคโดยการช่วยให้สิ่งมีชีวิตสามารถเจาะเนื้อเยื่อและติดเชื้อหลังจากการผ่าตัดหรือ
อื่น ๆ การบาดเจ็บ อุบัติการณ์ของการติดเชื้อโดยสิ่งมีชีวิตเหล่านี้สามารถลดหรือกาจัดได้ดีที่สุดโดยการ
หลีกเลี่ยงสภาวะที่ช่วยลดศักยภาพในการเกิดสาร redox ของเนื้อเยื่อและโดยการป้องกันการนาเชื้อ
anaerobes เข้าไปในเนื้อเยื่อที่ถูกทาลาย
68. Bacteroides เป็น แบคทีเรียที่ ไม่ใช้ออกซิเจนเป็น แบคทีเรีย ชนิด Gram-negative ชนิด Bacteroides เป็นแบคทีเรียรูป
แบบ endospore ไม่ใช่และอาจเป็น motile หรือ nonmotile ขึ้นอยู่กับชนิด องค์ประกอบของดีเอ็นเอคือ 40-48% GC ผิดปกติ
ในแบคทีเรียเชื้อแบคทีเรีย Bacteroides มี sphingolipids พวกเขายังมี กรด meso-diaminopimelic ในชั้น peptidoglycan
โดยปกติ แบคทีเรีย เหล่านี้จะมีส่วนร่วม ซึ่งทาให้เกิดส่วนสาคัญที่สุดของ ระบบทางเดินอาหารในสัตว์เลี้ยงลูกด้วยนม ซึ่งมีบทบาท
สาคัญในการประมวลผลโมเลกุลที่สลับซับซ้อนไปจนถึงลาไส้เล็กที่ง่ายกว่า ได้รับรายงานถึง 10 10 -10 11 เซลล์ต่อกรัมของ
อุจจาระมนุษย์ พวกเขาสามารถใช้ น้าตาลอย่างง่าย อย่างไรก็ตามแหล่งพลังงานหลักสาหรับสายพันธุ์ Bacteroides ในลาไส้
ใหญ่เป็นลาไส้ใหญ่ที่ได้รับจากพืช การศึกษาแสดงให้เห็นว่าอาหารในระยะยาวมีความสัมพันธ์อย่างมากกับองค์ประกอบของ
จุลินทรีย์ในกระเพาะอาหาร ผู้ที่กินโปรตีนและไขมันสัตว์จานวนมากมี แบคทีเรีย Bacteroides ส่วนใหญ่ในขณะที่ผู้ที่กิน
คาร์โบไฮเดรตมากขึ้นจะมีส่วนสาคัญในสายพันธุ์ Prevotella [9]
หนึ่งในสิ่งที่สาคัญที่สุดคือ Bacteroides fragilis ทางคลินิก
Bacteroides
69. สายพันธุ์ Bacteroides ยังเป็นประโยชน์ ยกเว้นเชื้อโรคที่อาจเกิดขึ้นจากการตั้งรกรากลาไส้เล็ก บางชนิด
( B. fragilis ) เป็น เชื้อโรคในมนุษย์ที่ทาให้เกิดการติดเชื้อในโพรงช่องท้องการผ่าตัดระบบทางเดินอาหารและ
ไส้ติ่งอักเสบ โดยการสร้างฝีก่อให้เกิดการยับยั้ง phagocytosis และการใช้ ยาปฏิชีวนะ beta-lactam
ถึงแม้ว่า แบคทีเรีย ชนิด Bacteroides จะเป็นแบบไม่ใช้ออกซิเจนพวกมันจะมีความสามารถในการ สลายตัว
ชั่วคราว ( aerotolerant) และสามารถอยู่รอดได้ในช่องท้อง
โดยทั่วไป Bacteroides มีความทนทานต่อ ยาปฏิชีวนะที่ หลากหลายเช่น beta-lactams,
aminoglycosides และเมื่อเร็ว ๆ นี้หลายสายพันธุ์ได้รับความต้านทานต่อ erythromycin และ tetracycline
ระดับความต้านทานยาปฏิชีวนะในระดับสูงนี้ทาให้เกิดความวิตกกังวลว่า แบคทีเรีย ชนิด Bacteroides อาจ
กลายเป็นแหล่งสะสมความต้านทานต่อเชื้อแบคทีเรียอื่น ๆ ที่ทาให้เกิดโรคได้ มีความไวต่อยา clindamycin
Bacteroides
70. Prevotella เป็น แบคทีเรียแกรมลบ เป็นสมาชิกของช่องปากและ ช่องคลอด และจะฟื้นตัวจาก การติดเชื้อ ในระบบทางเดิน
หายใจ แบบไม่ใช้ออกซิเจน การติดเชื้อเหล่านี้ ได้แก่ ปอดบวมความปั่นป่วนฝีฝีในปอด pulmonary empyema และโรค
หูน้าหนวกอักเสบเรื้อรังและโรคไซนัสอักเสบ พวกเขาได้รับการแยกจาก ฝี และการเผาไหม้ในบริเวณใกล้เคียงของปาก, กัด ,
paronychia , การติดเชื้อทางเดินปัสสาวะ , ฝีในสมอง โรคกระดูก และโรคติดเชื้อ แบคทีเรียที่ เกี่ยวข้องกับการติดเชื้อ
ทางเดินหายใจส่วนบน Prevotella spp. มีส่วนสาคัญในโรคปริทันต์และฝีฝีปริทันต์ ในการศึกษาแบคทีเรียในกระเพาะ
อาหารของเด็กใน Burkina Faso (ในแอฟริกา) Prevotella สร้างขึ้น 53% ของแบคทีเรียในกระเพาะอาหาร แต่ไม่พบใน
เด็กที่เป็นเด็กในยุโรป การศึกษาแสดงให้เห็นว่าอาหารในระยะยาวมีความสัมพันธ์อย่างมากกับองค์ประกอบของจุลินทรีย์ใน
ลาไส้ซึ่งผู้ที่กินโปรตีนและไขมันจากสัตว์ทั่วไปมักมี แบคทีเรีย Bacteroides ในขณะที่ผู้ที่บริโภคคาร์โบไฮเดรตมากขึ้น
โดยเฉพาะเส้นใยอาหาร สายพันธุ์ Prevotella
P. copri มีความสัมพันธ์กับการเริ่มเกิด โรคข้ออักเสบรูมาตอยด์
Prevotella
71. Drug resistant pathogens
MRSA ย่อมาจาก methicillin-resistant Staphylococcus aureus เป็นการติดเชื้อ Staph ชนิดหนึ่ง
ที่มีการดื้อต่อยาปฏิชีวนะที่มักใช้ในการรักษาการติดเชื้อ Staph ทั่วไป เมื่อแบคทีเรียเกิดการดื้อยา จะทา
ให้การกาจัดเชื้อเป็นไปได้ยากขึ้นและใช้เวลานานขึ้นในการฟื้นตัวจากการติดเชื้อ เชื้อ Staphylococcus มี
มากกว่า 30 สายพันธุ์แต่สายพันธุ์ที่พบได้บ่อยที่สุดคือ Staphylococcus aureus
ชนิดของเชื้อ MRSA
เชื้อ MRSA มี 2 ประเภท คือ กลุ่มที่เกิดจากการติดเชื้อในโรงพยาบาล (HA-MRSA) และกลุ่มที่เกิดจาก
การติดเชื้อในชุมชน (CA-MRSA) โดย HA-MRSA มักเกิดในกลุ่มผู้ป่วยที่อาศัยอยู่ในสถานพยาบาลเช่น
โรงพยาบาล ศูนย์ดูแลผู้ป่วยหรือศูนย์ล้างไต และ CA-MRSA ติดต่อผ่านทางการสัมผัส หรือในที่ๆ แออัดเช่น
ในโรงเรียนมัธยม นักกีฬามหาวิทยาลัย ผู้ที่อาศัยในหอพัก คุก หรือค่ายทหารจะมีความเสี่ยงในการติดเชื้อ
MRSA ที่สูงขึ้น
72. MDR ความต้านทานต่อยาหลายชนิด ( MDR ) ความต้านทานต่อยา multidrug หรือ multiresrug
คือ ความต้านทานต่อยาต้านจุลชีพที่แสดงโดยชนิดของ จุลินทรีย์ ต่อยาต้านจุลชีพหลายชนิด ประเภทที่เป็น
อันตราย ต่อสุขภาพ ส่วนใหญ่เป็น แบคทีเรีย MDR ที่ต่อต้าน ยาปฏิชีวนะหลายชนิด ชนิดอื่น ๆ ได้แก่ ไวรัส
MDR เชื้อรา และ ปรสิต (ทนต่อ ยาต้านเชื้อรา ไวรัส และ antiparasitic หลาย ชนิดของสารเคมีชนิดต่างๆ)
ตระหนักถึงระดับที่แตกต่างกันของ MDR ข้อกาหนดที่ ครอบคลุมยาเสพติดอย่างกว้างขวาง
( XDR ) และ pandrug-resistant ( PDR ) ได้รับการแนะนา คาจากัดความถูกตีพิมพ์ในปี 2011 ใน
วารสาร Clinical Microbiology and Infection และสามารถเข้าถึงได้โดยเปิดเผย
73. Pathonic acterial
Treponema pallidum
ซิฟิลิส Syphilis
เป็นโรคที่เกิดจากเชื้อแบคทีเรียที่เรียกว่า Treponema pallidum เชื้อนี้สามารถเข้าสู่ร่างกายทางเยื่อเมือกเช่น
ช่องคลอด ท่อปัสสาวะ ปาก เยื่อบุตา หรือทางผิวหนังที่มีแผล เมื่อเชื้อเข้าสู่ร่างกายจะเข้ากระแสเลือด และไปจับ
ตามอวัยวะต่างๆทาให้เกิดโรคตามอวัยวะและทาให้เกิดโรคแทรกซ้อนในระยะยาว โรคนี้แบ่งออกเป็น 4 ระยะ
ได้แก่
Primary
Secondary
Latent
Tertiary (or late)
74. อาการของโรค
1 Primary Syphilis
ในระยะ primary รอยโรคจะปรากฏเป็นแผลริมแข็ง Chancre ซึ่งจะมีลักษณะที่สาคัญดังนี้
แผลซิฟิลิส
หลังจากได้รับเชื้อ 10-90 วันโดยเฉลี่ยประมาณ 21 วัน จะมีตุ่มแดงแตกออกเป็นแผลที่อวัยวะเพศ ตรงบริเวณที่
เชื้อเข้า แผลมักจะเป็นแผลเดียว ไม่เจ็บ ขอบนูน ต่อมน้าเหลืองจะโตกดไม่เจ็บ
ตาแหน่งที่พบได้บ่อยได้แก่ อวัยวะเพศชาย อัณฑะ ทวารหนัก ช่องคลอด ริมฝีปาก
แผลจะอยู่ 1-5 สัปดาห์แผลจะหายไปเอง
แม้ว่าแผลจะหายไปแต่ยังคงมีเชื้ออยู่ในกระแสเลือด
สาหรับผู้ที่เป็นโรคเอดส์ และมีขนาดใหญ่และมีอาการเจ็บมาก
การตรวจเลือกในช่วงนี้อาจจะให้ผลลบได้ร้อยละ 30
75. 2 Secondary Syphilis
ระยะนี้จะเกิดหลังได้รับเชื้อ 17วัน- 6 เดือนผู้ป่วยจะมีอาการอยู่ประมาณ 2-6 สัปดาห์แล้วจะหายไปแม้ว่าจะ
ไม่ได้รับการรักษา
ต่อมน้าเหลืองโต ปวดตามข้อเนื่องจากข้ออักเสบ
อาการที่สาคัญมีดังนี้
ผื่นที่ผ่ามือ แผลริมแข็ง มีผื่นสีแดงน้าตาลที่ฝ่ามือ ฝ่าเท้า ไม่คัน ผื่นนี้สามารถพบได้ทั่วตัว ทั้งฝ่ามือ ฝ่าเท้า
จะพบหูด Condylomata lata บริเวณที่อับชื้น เช่นรักแร้ ทวารหนัก ขาหนีบ
จะพบผื่นสีเทาในปาก คอ และปากมดลูก ผมร่วงเป็นหย่อมๆ ผู้ป่วยจะรู้สึกไม่สบาย
อาการเหล่านี้จะอยู่ได้ 1-3 เดือนหายไปได้เอง และอาจจะกลับเป็นซ้า
การตรวจเลือดในช่วงนี้จะให้ผลบวก
76. 3 Latent Stage ระยะแฝง
ช่วงนี้ผู้ป่วยไม่มีอาการของโรค ช่วงนี้กินเวลา 2-30 ปีหลังจากได้รับเชื้อ
ในช่วงนี้จะทราบได้โดยการเจาะเลือดตรวจ
ในระยะนี้อาจจะเกิดผื่นเหมือนในระยะ Secondary Syphilis
ในระยะนี้หากตั้งครรภ์ เชื้อสามารถติดไปยังลูกได้
4 Late Stage (Tertiary)
ระยะนี้จะกินเวลา 2-30 ปีหลังได้รับเชื้อ
ระยะนี้เชื้อโรคจะทาลายอวัยวะต่างๆเช่น หัวใจและหลอดเลือด สมองทาให้อ่อนแรงหรืออาจจะตาบอด
กระดูกหักง่าย
หากไม่รักษาให้ทัน อวัยวะต่างๆจะถูกทาลายโดยที่ไม่สามารถกลับเป็นปกติ
การตรวจเลือดอาจจะให้ผลลบได้ร้อยละ30
77. เลปโตสไปโรซิส (Leptospirosis ), Weil 's disease, โรคฉี่หนู
โรคแทรกซ้อน ผู้ป่วยจะมีอาการดีซ่าน มีเลือดออกตามอวัยวะภายในและตา เยื่อหุ้มสมองอักเสบ นอกจากนี้ยังมี
อาการทางระบบทางเดินหายใจ
กลุ่มจุลินทรีย์ก่อโรค
โรคเลปโตสไปโรซิส เกิดจากเชื้อเลปโตสไปราใน Order Spirochaetales Genus Leptospira
เชื้อก่อโรคคือ Leptospira interrogans ซึ่งถูกจาแนกได้ 23 serogroup และมากกว่า 200 serovars
ลักษณะของเชื้อ
Leptospira interrogans เป็นแบคทีเรียรูปเกลียวสว่าน (Spirochete) ซึ่งมีขนาดเล็กมาก มอง
ด้วยตาเปล่าไม่เห็นแต่จะเห็นได้ด้วยกล้องจุลทรรศน์พื้นมืด (dark-field microscope) หรือกล้องจุลทรรศน์
ระบบเรืองแสง เมื่อย้อมสีพิเศษ เชื้อนี้มีขนาดเส้นผ่าศูนย์กลาง 0.1 ไมครอน และความยาวประมาณ 6 - 20
ไมครอน เคลื่อนไหวได้รวดเร็ว
Leptospira interrogans
78. Leptospira interrogans
กลุ่มอาการ
อาการแสดงของผู้ป่วยมีหลากหลายตั้งแต่ไม่แสดงอาการ จนกระทั่งอาการรุนแรงถึงเสียชีวิต โดยมีอาการ
คล้ายโรคติดเชื้ออื่น ๆ หลายโรค เช่น ไข้หวัดใหญ่ ไข้สมองอักเสบ ไทฟอยด์ ริกเกตเซีย เมลิออยโดสิส โรคนี้
จัดอยู่ในกลุ่มโรคที่นาโดยสัตว์ (Zoonosis) หรือ กลุ่มอาการไข้ไม่ทราบสาเหตุ
อาการที่แสดง
ระยะฟักตัวประมาณ 2 - 20 วัน ผู้ป่วยจะมีอาการแตกต่างกันขึ้นกับชนิดและปริมาณของเชื้อ อาการที่
พบบ่อยได้แก่ ไข้หนาวสั่น ปวดศีรษะรุนแรง ปวดกล้ามเนื้ออย่างรุนแรง มักปวดที่น่องและโคนขา อาจมีไข้
ติดต่อกันหลายวัน สลับกับระยะไข้ลด ในรายที่มีอาการรุนแรงเฉียบพลัน ผู้ป่วยจะมีอาการดีซ่าน มีเลือดออกตาม
อวัยวะภายในและตา เยื่อหุ้มสมองอักเสบ นอกจากนี้ยังมีอาการทางระบบทางเดินหายใจ มีอาการไอ หายใจขัด
ไอเป็นเลือด ตับและไตวาย ซึ่งจะทาให้ผู้ป่วยเสียชีวิตได้
79. Leptospira interrogans
อาการสาคัญแทรกซ้อน
อาจเกิดที่อวัยวะสาคัญต่างๆได้ดังนี้
ปอดบวม หัวใจล้มเหลว กล้ามเนื้ออักเสบ สมองและไขสันหลังอักเสบ Guillain-Barre syndrome (เป็นกลุ่มอาการไข้และ
เส้นประสาทหลายเส้นอักเสบอย่างเฉียบพลัน) Reye's syndrome (กลุ่มอาการที่มีพยาธิสภาพทางสมองและเสื่อมสลายของไขมัน
ในตับ) และกล้ามเนื้อและเยื่อหุ้มหัวใจอักเสบ
ไต เป็นภาวะแทรกซ้อนที่พบได้บ่อยที่สุด และเป็นสาเหตุของการเสียชีวิต ความผิดปกติพบตั้งแต่ความผิดปกติของปัสสาวะ
อย่างเดียวจนถึงไตวายมักพบไข่ขาวในปัสสาวะทุกระยะของโรค อาจตรวจพบ pyuria, hematuria
ตา ภาวะเยื่อบุตาบอมแดง เป็นอาการแสดงที่พบในระยะติดเชื้อในกระแสเลือด และมักตรวจพบอาการกลัวแสง และ
เลือดออกที่เยื่อบุตาขาว
ตับ อาการเหลืองเป็นตัวบ่งชี้ความรุนแรงของโรคที่สาคัญ ตับมักจะโตขึ้น และกดเจ็บอาการเหลืองเกิดจากการของเซลล์ตับ
เอง มักจะไม่พบผู้ป่วยที่เสียชีวิตจากตับวาย อาการทางตับมักจะหายเป็นปกติ
นอกจากนี้ยังมีการแทรกซ้อนอย่างอื่น เช่น หัวใจ จะพบในผู้ป่วยที่มีอาการรุนแรง ทางปอดจะทาให้ผู้ป่วยไอเป็นเลือดและ
อาจเสียชีวิตจากการขาดออกซิเจน ภาวะเลือดออกเกิดได้ในทุกอวัยวะ คาดว่าเกิดจากความผิดปกติของเส้นเลือด การติดเชื้อนี้ใน
หญิงตั้งครรภ์อาจทาให้เกิดการแท้งได้
80. การติดต่อของเชื้อมาสู่คน
เชื้อ L. interrogans มีสัตว์หลายชนิดเป็นรังโรค (Reservoir) เช่น หนู หมู วัว ควาย สุนัข แมว
เป็นต้น เชื้อจะถูกขับออกมากับปัสสาวะสัตว์ แล้วปนเปื้อนอยู่ในสิ่งแวดล้อม เช่น แหล่งน้าขัง เชื้อโรคนี้เข้าสู่
ร่างกายคนโดยการไชเข้าทางผิวหนังที่มีรอยถลอก หรือไชผ่านผิวหนังที่เปียกชุ่มจนยุ่ย เยื่อเมือก มีอุบัติการสูง
ในผู้ที่สัมผัสดินและน้าเป็นเวลานาน ๆ เช่น ชาวไร่ ชาวนา กรรมกร คนจับปลา
การควบคุมป้องกัน
หลีกเลี่ยงการสัมผัสสิ่งแวดล้อมที่อาจปนเปื้อนเชื้อ เช่น สวมถุงมือ สวมรองเท้าบูทขณะทางานสัมผัสดิน
และน้า กาจัดหนูซึ่งเป็นสัตว์นาโรค ให้สุขศึกษาประชาสัมพันธ์กับประชาชน บางประเทศที่มีการระบาดสูงจะมี
การใช้วัคซีนในปศุสัตว์และสัตว์เลี้ยง
Leptospira interrogans
81. การวินิจฉัยโรคทางห้องปฏิบัติการ
การเพาะแยกเชื้อจาก Clinical specimen เช่นเลือด ปัสสาวะ และน้าเจาะไขสันหลังเพื่อแยกชนิด
serovars ของเชื้อ
การตรวจหาแอนติบอดีในซีรัม โดยปกติแอนติบอดีจะเพิ่มขึ้นในสัปดาห์ที่ 2 ขั้นสูงสุดได้ในสัปดาห์ที่ 3 ถึง 4
และคงอยู่เป็นเวลานาน ควรตรวจอย่างน้อย 2 ครั้ง ห่างกันประมาณ 1 สัปดาห์ การตรวจหาแอนติบอดีมีหลาย
วิธีเช่น Microscopic agglutination test (MAT) เป็นวิธีมาตรฐานที่ WHO กาหนดไว้ สาหรับตรวจหา
แอนติบอดี ที่จาเพาะต่อเชื้อเลปโตสไปรา และสามารถบอก serovar ได้ด้วย
นอกจากนี้ยังมีการตรวจหาแอนติบอดีอีกหลายชนิดที่ใช้เป็น screening test เช่น Latex
agglutination, Hemaggutination test (IHA), Immunofluorescent assay (IFA) และ Enzyme-
linked immunosorbent assay (ELISA)
Leptospira interrogans
82. 83.

![Burkholderia
กลุ่ม Burkholderia หมายถึงกลุ่มของ Gram-negative ที่มีอยู่ ทั่วไปแพร่หลาย แบคทีเรีย รูปแท่งซึ่งมี
ลักษณะ เป็น โมเลกุล เดียวหรือหลายขั้วยกเว้น Burkholderia mallei ซึ่งเป็น โมเลกุลที่ไม่ใช่ บิ วทิล สมาชิกที่เป็น
ของสกุลไม่ได้ผลิตปลอกหรือ prosthecae และสามารถใช้ โพลีเบต้า - ไฮดรอกซีบิวเทท (PHB) เพื่อการเจริญเติบโต
ได้ สกุลรวมทั้ง เชื้อโรค จากสัตว์และพืชรวมทั้งสายพันธุ์ที่มีความสาคัญต่อสิ่งแวดล้อม โดยเฉพาะอย่างยิ่ง B.
xenovorans (ก่อนหน้านี้ชื่อ Pseudomonas cepacia แล้ว B. cepacia และ B. fungorum ) มีชื่อเสียงในด้าน
catalase positive (มีผลต่อผู้ป่วยที่เป็น โรค granulomatous เรื้อรัง ) และความสามารถในการย่อยสลายสาร
กาจัดศัตรูพืชคลอโรนิกและ polyplorylated biphenyls ( PCBs ) โครงสราง RNA แบบอนุรักษ RNA anti-
hemB RNA พบไดในแบคทีเรียที่พบในสกุลนี้ [2]
เนื่องจากความต้านทานยาปฏิชีวนะและอัตราการเสียชีวิตสูงจากโรคที่เกี่ยวข้องของพวกเขา B. mallei และ B.
pseudomallei ถือเป็นตัวแทน สงครามทางชีวภาพที่ มีศักยภาพซึ่งมีเป้าหมายสาหรับปศุสัตว์และมนุษย์](https://image.slidesharecdn.com/presentation2-171210165109/85/Presentation2-39-320.jpg)










![Francisella tularensis เป็นเชื้อที่ก่อให้เกิดโรค ได้แก่ กาม แบคทีเรีย
ก้านรูปแท่ง ( Gram-negative coccobacillus ) ซึ่งเป็น แบคทีเรีย aerobe [1] เป็นสปอร์ที่ไม่ก่อตัวขึ้น
ไม่ใช่ตัวกระตุ้น และเป็นสาเหตุของ โรคไข้เหลือง ซึ่งเป็นรูปแบบของ pneumonic ซึ่งมักเป็นอันตรายถึงตายโดย
ไม่ได้รับการรักษา เป็นแบคทีเรียภายในเซลล์ ที่มีความซับซ้อนซึ่งจาเป็นต้องใช้ cysteine เพื่อการเจริญเติบโต
เนืองจากเชื้อโรคต่าแพร่กระจายได้ง่ายโดยละอองลอยและมี ความรุนแรง สูง
bioterrorism เช่น Yersinia pestis , Bacillus anthracis และไวรัส อีโบลา เมื่อพบในธรรมชาติ
Franciesella tularensis สามารถอยู่รอดได้เป็นเวลาหลายสัปดาห์ที่อุณหภูมิต่าในซากสัตว์ดินและน้า ใน
ห้องปฏิบัติการ Francisella tularensis จะปรากฏเป็นแท่งเล็ก ๆ (0.2 โดย 0.2 μm) และเติบโตได้ดีที่สุดที่
อุณหภูมิ 35-37 องศาเซลเซียส
Francisella tularensis](https://image.slidesharecdn.com/presentation2-171210165109/85/Presentation2-50-320.jpg)
![Francisella tularensis
ชนิดย่อย F. t. tularensis (หรือชนิด A) พบมากใน ทวีปอเมริกาเหนือ เป็นโรคที่รุนแรงที่สุดในสี่ชนิดย่อยที่รู้จักและ
เกี่ยวข้องกับการติดเชื้อในปอดที่ตายแล้ว ซึ่งรวมถึงสายพันธุ์หลักของห้องทดลอง A, SCHUS4
กลุ่มย่อย F. t. holarctica (เรียกอีกอย่างว่า biovar F. t. palearctica หรือชนิด B) พบมากใน ยุโรป และ เอเชีย
แต่ไม่ค่อยนาไปสู่โรคร้ายแรง สายพันธุ์ วัคซีนที่ ถ่ายทอดสดที่อ่อนแอของกลุ่มย่อย F. t holarctica ได้รับการอธิบายแม้ว่าจะยัง
ไม่ได้รับอนุญาตอย่างเต็มที่โดย องค์การอาหารและยา เป็นวัคซีน กลุ่มย่อยนี้ขาดกิจกรรม cytrelase และความสามารถในการ
ผลิตกรดจากน้าตาลกลูโคสของ Biovar F. t palearctica
กลุ่มย่อย F. t. novicida (จัดก่อนหน้านี้เป็น F. novicida [8] ) มีลักษณะเป็นสายพันธุ์ nonvirulent ค่อนข้าง; มี
เพียงสองกรณีโรคโลหิตจางในทวีปอเมริกาเหนือมีสาเหตุมาจาก F. t novicida และเหล่านี้เป็นเฉพาะในบุคคลที่ มีภูมิคุ้มกัน
บกพร่อง อย่างรุนแรง
กลุ่มย่อย F. t. mediasiatica พบมากที่สุดใน เอเชียกลาง ปัจจุบันมีเพียงเล็กน้อยที่รู้จักเกี่ยวกับเรื่องย่อยนี้หรือ
ความสามารถในการติดเชื้อของมนุษย์](https://image.slidesharecdn.com/presentation2-171210165109/85/Presentation2-51-320.jpg)















![อาการทางคลินิก
Gram-negative anaerobic bacilli อาจทาให้เกิดการติดเชื้อที่ใดก็ได้ในร่างกาย ชนิดที่พบมากที่สุดคือ
ช่องปากและฟัน ช่องท้อง pleuropulmonary ภายในช่องท้องอวัยวะเพศหญิงและผิวหนังเนื้อเยื่ออ่อนและ
การติดเชื้อของกระดูก อาจมีบทบาทในกระบวนการทางพยาธิวิทยาที่หลากหลาย เช่น โรคปริทันต์และ
มะเร็งลาไส้ใหญ่ Bacteroides, Prevotella Porphyromonas และ Fusobacterium ผลิตเอนไซม์
(collagenase, neuraminidase, deoxyribonuclease, deoxyribonuclease [DNase],
heparinase และ proteinase)
อาจมีบทบาทในการเกิดโรคโดยการช่วยให้สิ่งมีชีวิตสามารถเจาะเนื้อเยื่อและติดเชื้อหลังจากการผ่าตัดหรือ
อื่น ๆ การบาดเจ็บ อุบัติการณ์ของการติดเชื้อโดยสิ่งมีชีวิตเหล่านี้สามารถลดหรือกาจัดได้ดีที่สุดโดยการ
หลีกเลี่ยงสภาวะที่ช่วยลดศักยภาพในการเกิดสาร redox ของเนื้อเยื่อและโดยการป้องกันการนาเชื้อ
anaerobes เข้าไปในเนื้อเยื่อที่ถูกทาลาย](https://image.slidesharecdn.com/presentation2-171210165109/85/Presentation2-67-320.jpg)
![Bacteroides เป็น แบคทีเรียที่ ไม่ใช้ออกซิเจนเป็น แบคทีเรีย ชนิด Gram-negative ชนิด Bacteroides เป็นแบคทีเรียรูป
แบบ endospore ไม่ใช่และอาจเป็น motile หรือ nonmotile ขึ้นอยู่กับชนิด องค์ประกอบของดีเอ็นเอคือ 40-48% GC ผิดปกติ
ในแบคทีเรียเชื้อแบคทีเรีย Bacteroides มี sphingolipids พวกเขายังมี กรด meso-diaminopimelic ในชั้น peptidoglycan
โดยปกติ แบคทีเรีย เหล่านี้จะมีส่วนร่วม ซึ่งทาให้เกิดส่วนสาคัญที่สุดของ ระบบทางเดินอาหารในสัตว์เลี้ยงลูกด้วยนม ซึ่งมีบทบาท
สาคัญในการประมวลผลโมเลกุลที่สลับซับซ้อนไปจนถึงลาไส้เล็กที่ง่ายกว่า ได้รับรายงานถึง 10 10 -10 11 เซลล์ต่อกรัมของ
อุจจาระมนุษย์ พวกเขาสามารถใช้ น้าตาลอย่างง่าย อย่างไรก็ตามแหล่งพลังงานหลักสาหรับสายพันธุ์ Bacteroides ในลาไส้
ใหญ่เป็นลาไส้ใหญ่ที่ได้รับจากพืช การศึกษาแสดงให้เห็นว่าอาหารในระยะยาวมีความสัมพันธ์อย่างมากกับองค์ประกอบของ
จุลินทรีย์ในกระเพาะอาหาร ผู้ที่กินโปรตีนและไขมันสัตว์จานวนมากมี แบคทีเรีย Bacteroides ส่วนใหญ่ในขณะที่ผู้ที่กิน
คาร์โบไฮเดรตมากขึ้นจะมีส่วนสาคัญในสายพันธุ์ Prevotella [9]
หนึ่งในสิ่งที่สาคัญที่สุดคือ Bacteroides fragilis ทางคลินิก
Bacteroides](https://image.slidesharecdn.com/presentation2-171210165109/85/Presentation2-68-320.jpg)














